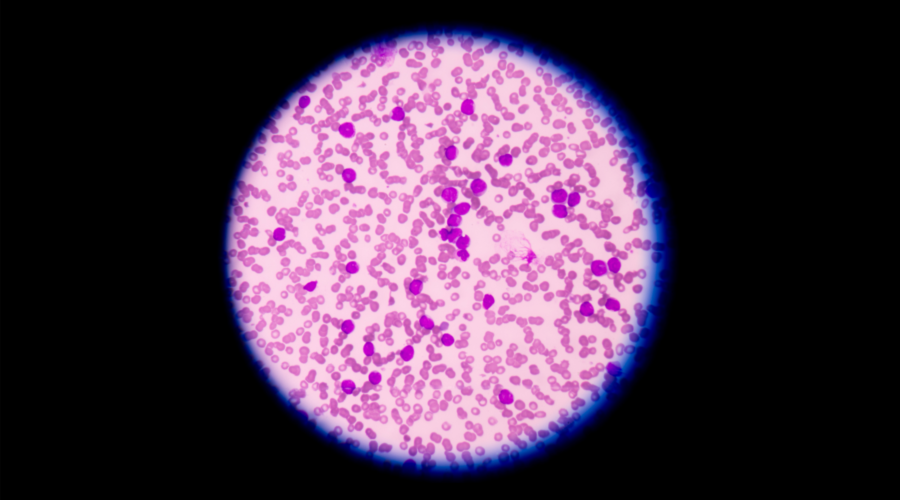

-
30 juin 2026 Les récipiendaires du Concours IRIC scientifiques de demain 2026 rejoignent l’Institut!
Cet été, 12 étudiantes et étudiants ont l’opportunité de compléter un stage de recherche de 12 ou de 16 semaines à l’IRIC, en plus de bénéficier d’une bourse d’excellence.
![]()
-
29 juin 2026 Michel Bouvier nommé Officier de l’Ordre du Canada
Le professeur Michel Bouvier, directeur de l’Unité de recherche en pharmacobiologie moléculaire de l’IRIC, a été nommé Officier de l’Ordre du Canada par la gouverneure générale.
![]()
-
22 juin 2026 Concours de recrutement étudiant 2026 : à la rencontre des talents scientifiques de demain!
Le Concours de recrutement étudiant de l’IRIC offre chaque année aux étudiantes et étudiants intéressés à mener des études supérieures en recherche sur le cancer une opportunité unique de participer à un événement de recrutement international à Institut de recherche en immunologie et en cancérologie de l’Université de Montréal.
![]()
-
18 juin 2026 Plus d’un million de dollars en subvention pour Michel Bouvier et la jeune pousse Drave Therapeutics
L’équipe de Michel Bouvier, directeur de l’Unité de recherche en pharmacologie moléculaire de l’IRIC, obtient 1,08 M$ pour un projet en pharmacologie de précision des récepteurs couplés aux protéines G (RCPG). Cet octroi est soutenu par le Consortium québécois sur la découverte du médicament (CQDM), par l’entremise du Ministère de l’Économie, de l’Innovation et de l’Énergie du Québec, et par les partenaires de cofinancement Drave Therapeutics et l’Université de Montréal.
![]()
-
10 juin 2026 Claude Perreault nommé Chevalier de l’Ordre national du Québec
Le 17 juin prochain, le professeur Claude Perreault, directeur de l’Unité de recherche immunobiologie de l’IRIC, sera décoré du grade de Chevalier de l’Ordre national du Québec.
![]()
-
5 juin 2026 Un « super-squelette » qui transmet les forces mécaniques à la surface des cellules
L’équipe de Gregory Emery, directeur de l’Unité de recherche en transport vésiculaire et signalisation cellulaire de l’IRIC, a identifié une structure dynamique qui forme un réseau à la surface des cellules épithéliales. Le travail, mené par les doctorantes Claire Baudouin et Léa Marpeaux, fait l’objet d’une publication dans le Journal of Cell Science. L’article a fait la couverture du journal et est accompagné d’une entrevue avec les deux étudiantes.
![]()
-
1er juin 2026 Rencontrez Marie-Anne Goyette, nouvelle chercheuse principale à l’IRIC!
![]()
-
1er juin 2026 Gala Audace de l’IRIC : 1 130 000$ amassés pour la recherche en cancérologie
Le 21 mai dernier avait lieu l’édition 2026 du Gala Audace de l’Institut de recherche en immunologie et en cancérologie (IRIC) de l’Université de Montréal. Grâce à la générosité de plus de 300 convives rassemblés au Marché Bonsecours, de nos précieux donateurs et donatrices, et de nos commanditaires, une somme remarquable de 1 130 000$ a été amassée pour soutenir la recherche en cancérologie à l’IRIC.
![]()
-
15 mai 2026 Guy Sauvageau honoré par le Réseau de Cellules Souches
Le professeur Guy Sauvageau, directeur de l’Unité de recherche en génétique moléculaire des cellules souches, reçoit le Prix de l’avant-gardiste du Réseau de Cellules Souches. Ce prix récompense les personnes qui ont relevé des défis majeurs dans le domaine de la médecine régénératrice et qui ont mis au point des solutions qui font progresser les soins, les politiques, la commercialisation ou l’innovation d’un système.
![]()
-
6 mai 2026 Guy Sauvageau nommé chevalier de l’Ordre de Montréal
Le 8 mai prochain, le professeur Guy Sauvageau, directeur de l’Unité de recherche en génétique moléculaire des cellules souches de l’IRIC, se verra remettre les insignes de l’Ordre de Montréal à titre de chevalier.
![]()
-
30 avril 2026 RIMap-RISC : une nouvelle interface pour étudier la biologie des ARN
L’équipe de François Major, directeur de l’Unité de recherche en ingénierie des ARN de l’IRIC, a développé la nouvelle base de données RIMap-RISC qui intègre la structure moléculaire des microARN et des ARN messagers pour modéliser systématiquement leurs interactions. Mené par le doctorant Simon Chasles, ce travail fait l’objet d’une publication dans Genome Biology.
![]()
-
8 avril 2026 L’équipe de Marc Therrien remporte le prix Découverte de l’année 2025 - Québec Science
L’équipe de Marc Therrien, chercheur principal et directeur général de l’IRIC s’est vue décerner le prix de la Découverte de l’année 2025 du magazine Québec Science pour ses travaux sur la protéine BRAF et son rôle dans la propagation des cellules cancéreuses. C’est le public qui a désigné le lauréat, plus de 2 000 personnes ayant participé au vote.
![]()
-
31 mars 2026 À la recherche de nouveaux antibiotiques pour combattre l’antibiorésistance
L’Unité de découverte de médicaments (UDM2) de l’IRIC fait partie du projet « Conception d’antibiotiques ciblant Klebsiella grâce à l’intelligence artificielle », qui a obtenu 3,8 M$ US (soit environ 5,3 M$ CA) de la Fondation Gates.
![]()
-
25 mars 2026 Un modèle de collaboration biopharmaceutique moderne — le partenariat durable entre Ipsen, l’IRIC et IRICoR
À une époque où les avancées scientifiques majeures reposent de plus en plus sur des collaborations profondes et intersectorielles, le partenariat de longue date entre Ipsen et les équipes de l’Institut de recherche en immunologie et en cancérologie (IRIC) de l’Université de Montréal, ainsi que de la société de valorisation IRICoR, s’impose comme un modèle de coopération efficace entre le monde académique et l’industrie pour accélérer la science de manière ciblée. Initié en 2020 et renouvelé à deux reprises depuis, ce partenariat porte aujourd’hui sur quatre programmes actifs de recherche en oncologie. Pierre Beaulieu, directeur adjoint de l’Unité de découverte de médicaments à l’IRIC, Hugo Lavoie, directeur adjoint de l’Unité de recherche en signalisation intracellulaire de l’IRIC, et Chris Hupp, Senior Director, Research & External Innovation chez Ipsen, expliquent comment cette collaboration est passée d’une alliance prometteuse à un véritable moteur de développement de thérapies transformatrices pour les patients.
![]()
-
23 mars 2026 Rencontrez Simon-Pierre Gravel, nouveau chercheur principal à l’IRIC!
L’IRIC est fier de souligner l’arrivée de Simon-Pierre Gravel comme nouveau chercheur principal de recherche à l’Unité de recherche en métabolisme et signalisation du cancer. Simon-Pierre Gravel a généreusement accepté de répondre à quelques questions
![]()
-
11 mars 2026 Patient(e)s et scientifiques : avancer ensemble contre les cancers du sang!
Le jeudi 25 février dernier, l’IRIC a accueilli des patient(e)s atteint(e)s de leucémie ou de lymphome pour un moment unique de partage entre les étudiant(e)s et les scientifiques de l’Institut : une occasion de mettre en lumière les personnes atteintes d’un cancer au cœur de la recherche
![]()
-
26 février 2026 Un financement pour rendre la recherche en bio-informatique faite à l’IRIC plus écoresponsable
L’équipe des technologies de l’information (TI) de l’IRIC a obtenu un financement du Vice-rectorat à la recherche et à l’innovation de l’Université de Montréal pour le remplacement d’unités de refroidissements désuètes par des modèles moins énergivores.
![]()
-
11 février 2026 Trang Hoang, celle qui place l’humain au centre de la recherche scientifique
À l’IRIC, tout le monde connaît la chercheuse Trang Hoang. L’une des fondatrices de l’Institut, elle y dirige depuis 2003 l’Unité de recherche en hématopoïèse et leucémie. Son engagement, sa passion et son talent pour la collaboration ont bénéficié à de multiples générations de chercheurs, chercheuses, étudiants et étudiantes au fil des ans. En cette Journée internationale des femmes et des filles de sciences, prenons un moment pour braquer les projecteurs sur la carrière de cette bâtisseuse.
![]()
-
10 février 2026 Félicitations aux récipiendaires du Concours de Bourses de maitrise et doctorat de l’IRIC!
Ces bourses ont été remises grâce à l’engagement de donateur(rice)s fidèles. Merci de votre générosité !
![]()
-
4 février 2026 Thérapie cellulaire UM171 : La science à la rencontre de l’humain
En cette Journée mondiale contre le cancer, Anne Marinier, directrice de l’Unité de découverte de médicaments de l’IRIC s’entretient avec Pasquale Gentile, un patient guéri par la thérapie cellulaire UM171 développée à l’IRIC. Une rencontre riche et empreinte d’humanité qui donne espoir en la recherche contre le cancer.
![]()
-
21 janvier 2026 Delphine Bouilly reconnue par la Société royale du Canada et le Gouvernement du Québec
La professeure Delphine Bouilly, qui dirige l’Unité de recherche en conception et application de nanobiocapteurs électroniques de l’IRIC, s’est méritée deux distinctions de prestige au cours des derniers mois grâce à l’envergure de ses travaux de recherche. Delphine Bouilly a été finaliste du prix Hubert-Reeves des Prix du Québec 2025. Elle a également intégré le Collège des nouveaux chercheurs et créateurs en art et en science de la Société royale du Canada (SRC). Ces honneurs s’ajoutent à un palmarès bien garni qui n’a de cesse de se bonifier depuis le recrutement de la chercheuse en 2017.
![]()
-
8 janvier 2026 Une percée de l’IRIC parmi les 10 découvertes de l’année de Québec Science
L’équipe de Marc Therrien, directeur général et chercheur principal à l’IRIC, a percé un mystère fondamental de la biologie du cancer: elle a levé le voile sur la façon dont une protéine déréglée permet au cancer de proliférer dans le corps humain. Cette percée scientifique, publiée dans la revue Science, fait partie des 10 découvertes scientifiques les plus remarquables de l’année 2025 sélectionnées par le jury du magazine Québec Science.
![]()
-
15 décembre 2025 Rendre les cellules de cancer du sein plus visibles pour le système immunitaire
L’équipe de Pierre Thibault, directeur de l’Unité de recherche en protéomique et spectrométrie de masse de l’IRIC, a découvert que l’abemaciclib, utilisé pour traiter les cancers du sein métastatiques à récepteurs hormonaux positifs, reprogramme le profil antigénique des tumeurs – une caractéristique qui pourrait être exploitée pour améliorer l’efficacité des traitements. Menée par le doctorant Robin Minati, cette étude vient de paraître dans le journal Cell Reports. Elle résulte d’une étroite collaboration avec l’équipe de Claude Perreault, directeur de l’Unité de recherche en immunobiologie de l’IRIC.
![]()
-
18 novembre 2025 Un rôle inédit pour le pH dans la régulation des protéines
L’équipe de Sylvain Meloche, directeur de l’Unité de recherche en signalisation et croissance cellulaire de l’IRIC, a découvert un nouveau mécanisme de régulation globale des protéines par le pH intracellulaire. L’étude, co-menée par les doctorantes Chloé Tesnière et Fadia Boudghene-Stambouli, fait l’objet d’une publication dans le journal PNAS. Les équipes de Pierre Thibault, directeur de l’Unité de recherche en protéomique et spectrométrie de masse de l’IRIC, et de Laurent Counillon, directeur du Laboratoire de PhysioMédecine Moléculaire au CNRS-Université Côte d’Azur (Nice, France), et de Stine F. Pedersen de l’Université de Copenhague ont également contribué au projet.
![]()
-
14 novembre 2025 Journée nationale de la philanthropie : la parole à la jeunesse!
Le 15 novembre 2025 est la Journée nationale de la philanthropie à travers le Canada. Cette journée étant l’occasion d’honorer les philanthropes et leurs impacts sur la société; l’IRIC a choisi de mettre en lumière les récentes réalisations du comité des Jeunes Philanthropes de l’IRIC et de certains visages derrière le succès du comité. L’IRIC est fier de vous présenter deux des membres fondateurs : Katrina Kontaxis et Benjamin Raynauld.
![]()
-
11 novembre 2025 Un tournoi de pickleball haut en couleur pour les Jeunes Philanthropes au profit de l’IRIC!
C’est le 26 octobre dernier que s’est déroulé l’événement tant attendu des Jeunes Philanthropes de l’IRIC au Club Atwater. Au programme? Un tournoi de pickleball et un brunch distingué! Une formule audacieuse et parfaitement exécutée, qui a su rassembler 150 participant(e)s de la relève montréalaise, présent(e) pour la cause.
![]()
-
5 novembre 2025 Une équipe de l’IRIC présente à l’événement « Illumine la nuit » !
Le 25 octobre dernier, une équipe de près d’une trentaine de personnes de l’IRIC, a pris part à la marche « Illumine la nuit » organisée par la Société de Leucémie et Lymphomes du Canada.
![]()
-
3 novembre 2025 Félicitations aux récipiendaires du Concours science réflexion 2025!
L’IRIC a le plaisir de vous annoncer les gagnantes du concours Science Réflexion 2025. Ce concours annuel met en lumière la créativité et le talent de la communauté de l’IRIC.
![]()
-
29 octobre 2025 Delphine Bouilly et Madline Sauvage : améliorer le suivi et le traitement du cancer du sein
La doctorante en biologie moléculaire Madline Sauvage et la professeure Delphine Bouilly, directrice de l’Unité de recherche de conception et application de nanobiocapteurs électroniques de l’IRIC, sont lauréates d’une bourse Pierre-Péladeau. Leur jeune pousse SensÈn, dont la mission est de faire une différence clinique pour les patientes atteintes de cancer du sein, s’est effectivement mérité le 2e Prix de 50 000 $ lors de la 27e édition du concours. Ces bourses, offertes depuis 1999, visent à soutenir la relève de tous les domaines d’études pour le démarrage d’entreprises, la réalisation de plans d’affaires, et le développement de produits et de marchés.
![]()
-
29 octobre 2025 Eralda Kina : conjuguer la recherche et la clinique
Eralda Kina est oncologue de profession et étudiante au doctorat au sein du laboratoire de Claude Perreault, chercheur principal à l’Unité de recherche en immunobiologie de l’IRIC. L’équipe de Claude Perreault étudie les cellules qui régissent le fonctionnement du système immunitaire, que l’on appelle les « lymphocytes T », afin de comprendre et d’améliorer le fonctionnement du système immunitaire. L’objectif ultime de l’équipe est de développer des vaccins thérapeutiques contre le cancer.
![]()
-
29 octobre 2025 Entrevue avec Sylvie Mader - Étudier le cancer du sein : des motivations interreliées
L’équipe de Sylvie Mader, chercheuse principale à l’Unité de recherche en ciblage moléculaire dans le traitement du cancer du sein de l’IRIC, travaille à comprendre les causes de la diversité des sous-types de cancer du sein, à identifier de nouvelles cibles pour le développement de médicaments, et à comprendre les causes des résistances aux molécules utilisées pour traiter le cancer du sein.
![]()
-
29 octobre 2025 Entrevue avec Geneviève Deblois - Cap sur le cancer du sein
L’équipe de Geneviève Deblois, chercheuse principale à l’Unité de recherche des mécanismes épigénétiques et métabolisme du cancer de l’IRIC, étudie un sous-type particulièrement agressif de cancer du sein, appelé triple négatif, caractérisé par des taux élevés de rechute et un manque d’options thérapeutiques ciblées. Les patientes qui en sont atteintes sont la plupart du temps traitées par chimiothérapie, mais présentent de hauts taux de rechute. L’équipe cherche à comprendre comment ces cellules tumorales s’adaptent et survivent dans un microenvironnement appauvri en nutriments et en oxygène, ainsi que les mécanismes qui leur permettent de résister aux chimiothérapies, afin de concevoir de nouvelles stratégies thérapeutiques plus efficaces.
![]()
-
29 octobre 2025 Symposium 2025 de l’IRIC : la biologie spatiale sous toutes ses coutures
L’IRIC a tenu le 24 octobre dernier un symposium scientifique international qui a permis d’explorer les capacités des techniques de biologie spatiale. Plus de 150 membres de la grande communauté de recherche de l’IRIC, de Montréal et d’ailleurs se sont réunis pour échanger sur les plus récentes avancées en séquençage spatial, en pathologie computationnelle et en procédés analytiques.
![]()
-
20 octobre 2025 Courir pour la cause : à chacun son rythme!
Au début de l’été 2025, Mira-Sue Mallet, partenaire des ressources humaines à l’IRIC a joint pour la première fois le Club de course de l’IRIC. Ce qui ne devait être qu’une opportunité de se remettre en forme et de s’amuser entre collègues s’est transformé en réel accomplissement. Non seulement Mira-Sue a mis la main à la pâte pour lever des fonds pour la recherche; celle-ci s’est également engagée dans un premier 5 km au Marathon Beneva de Montréal, qu’elle a terminé avec fierté! L’IRIC vous présenter une collègue inspirante qui a su persévérer jusqu’au bout.
![]()
-
17 octobre 2025 Un don majeur de 750 000$ en soutien à la recherche en cancérologie
Le 1er octobre dernier, quatre fidèles donateurs et donatrices de l’IRIC, soit Mme Danielle Lysaught, M. Paul Hamelin, M. Nigel Hamer et M. Jean-Marc Rousseau ont reçu un sarrau à l’effigie de l’IRIC, un geste symbolique pour les remercier de leur dévouement constant envers la recherche menée à l’IRIC.
![]()
-
16 octobre 2025 Sébastien Lemieux et Carino Gurjao obtiennent un financement de la Fondation canadienne pour l’innovation (FCI) et du gouvernement du Québec
Sébastien Lemieux, chercheur principal et directeur scientifique de la plateforme de Bio-informatique de l’IRIC, de concert avec Carino Gurjao, chercheur principal à l’Unité de recherche en médecine génomique et intégrative également à l’Institut, sont récipiendaires d’une subvention de recherche de la Fondation canadienne pour l’innovation (FCI) au Fonds des leaders John-R.-Evans (FLJE) pour leur projet « Infrastructure destinée au développement d’approches informatiques pour la recherche sur le cancer », et ce, pour la période de mars 2025 à avril 2027.
![]()
-
16 octobre 2025 L’IRIC repart sur la route cet automne 2025!
Dans le cadre de sa tournée de recrutement étudiant IRIC sur la route, l’équipe des affaires académiques de l’Institut participera cet automne à plusieurs salons d’études supérieures organisés par des universités canadiennes
![]()
-
10 octobre 2025 Le Club de recherche clinique du Québec décerne un prix honorifique à Michel Bouvier
Dans le cadre de la réunion annuelle du Club de recherche clinique du Québec (CRCQ), Michel Bouvier s’est vu décerner le prix du mentor scientifique 2025. Cet honneur lui est attribué en raison de ses qualités exceptionnelles en tant que mentor, de son engagement auprès de nombreux étudiant(e)s formé(e)s, de la qualité de la formation et de sa passion envers la relève.
![]()
-
8 octobre 2025 À la rencontre d’Edouard Williams Brunet : un jeune ambassadeur dédié à la cause!
L’IRIC a eu la chance de s’entretenir avec Edouard William Brunet, coprésident du comité des Jeunes Philanthropes de l’IRIC. Ayant reçu le diagnostic d’un cancer au début de sa vingtaine, Edouard souhaite redonner à son tour en amassant des fonds pour la recherche. L’IRIC est fier de mettre en lumière cette personnalité inspirante.
![]()
-
6 octobre 2025 Près de 16 000$ amassés dans le cadre du Marathon Beneva de Montréal
La fin de semaine du 20 septembre dernier avait lieu le Marathon Beneva de Montréal. Fidèle partenaire de l’événement, l’IRIC a collecté près de 16 000$ pour la recherche en cancérologie grâce à 150 généreux contributeurs et contributrices.
![]()
-
2 octobre 2025 De l’idée à l’essai clinique : un ultra-marathon scientifique
Un jalon majeur a été franchi récemment avec le démarrage d’un essai clinique de phase 1 pour une thérapie à petite molécule pour les tumeurs solides, sous octroi à Ipsen. La molécule en question inhibe la protéine RAF, qui fait partie de la voie de signalisation pro-tumorale Ras-MAPK. Cette avancée a été rendue possible par la synergie entre les équipes d’Anne Marinier, directrice de l’Unité de découverte de médicaments de l’IRIC, et de Marc Therrien, directeur de l’Unité de recherche en signalisation intracellulaire et directeur général de l’IRIC.
Retour et explications sur le travail de longue haleine, initié chez la mouche à fruits et s’étalant sur plus de vingt ans, qui a permis d’atteindre la phase clinique :
![]()
-
25 septembre 2025 Carino Gurjao obtient un financement pour l’avancement de la recherche sur le cancer colorectal métastatique
Dans le cadre d’un appel à projets conjoint de Pfizer et Cancer colorectal Canada, Carino Gurjao, chercheur principal à l’Unité de recherche en médecine génomique et intégrative de l’IRIC est récipiendaire d’un montant de près de 100 000$ pour son projet « A Nanopore Sequencing Approach for Real-time Precision Medicine ».
![]()
-
11 septembre 2025 Les laboratoires de Delphine Bouilly, Sylvie Mader et Sébastien Lemieux obtiennent une subvention importante du gouvernement fédéral
L’équipe de Delphine Bouilly, en collaboration avec celles de Sylvie Mader et Sébastien Lemieux, obtient un financement important du Fonds Nouvelles frontières en recherche du gouvernement du Canada – volet Exploration, pour son projet « Exploiting Electrolytic Gating in Graphene Field-Effect Nanosensors to Achieve Multiplexed Breast Cancer Profiling for Personalized Medicine ».
![]()
-
8 septembre 2025 Deux chercheurs de l’IRIC obtiennent un financement du Conseil de recherches en sciences naturelles et en génie du Canada (CRSNG)
En 2025, dans le cadre du Programme de subventions à la découverte, le CRSNG a octroyé un financement important sur cinq ans à l’équipe de Philippe Roux, à la tête de l’Unité de recherche en signalisation cellulaire et protéomique; ainsi qu’à l’équipe de Matthew Smith, qui dirige l’Unité de recherche en signalisation cellulaire et biologie structurale.
![]()
-
2 septembre 2025 L’IRIC et la Faculté de pharmacie de l’UdeM recrutent Olivier Mailhot à titre de chercheur principal
L’IRIC est fier de souligner l’arrivée d’Olivier Mailhot comme nouveau chercheur principal à l’Unité de recherche en découverte computationnelle du médicament. Celui-ci occupera le poste de professeur adjoint à la Faculté de pharmacie de l’Université de Montréal (UdeM). Olivier Mailhot a également été nommée professeur IVADO.
![]()
-
2 septembre 2025 Rencontrez Olivier Mailhot, nouveau chercheur à l’IRIC
L’IRIC est fier de souligner l’arrivée d’Olivier Mailhot comme nouveau chercheur principal à l’Unité de recherche en découverte computationnelle du médicament. Le professeur Mailhot a généreusement accepté de répondre à quelques questions :
![]()
-
28 août 2025 Marc Therrien élu membre à l’Académie canadienne des sciences de la santé
Marc Therrien, chercheur principal à l’Unité de recherche en signalisation intracellulaire et directeur général de l’IRIC; ainsi que professeur titulaire au Département de pathologie et biologie cellulaire de la Faculté de médecine de l’Université de Montréal, rejoint l’Académie canadienne des sciences de la santé (ACSS) en tant que nouveau membre. Au total, 47 nouveaux élus joignent les rangs de l’ACSS pour l’année 2025.
![]()
-
22 août 2025 L’IRIC met en lumière le savoir scientifique de la relève!
La 7e édition de la Journée des stagiaires d’été de l’IRIC 2025 s’est tenue le jeudi 7 août dernier.
![]()
-
12 août 2025 Un travail de l’ombre mis en lumière : une récompense des IRSC pour les chercheurs Gregory Emery et David Knapp
Gregory Emery et David Knapp, respectivement directeurs de l’Unité de recherche en transport vésiculaire et signalisation cellulaire et de l’Unité de recherche en ingénierie cellulaire de l’IRIC, ont tous deux reçu une mention de contribution exceptionnelle du Collège des évaluateurs des Instituts de recherche en santé du Canada (IRSC). De plus, il a été déterminé que Gregory Emery a rendu un service d’évaluation exceptionnel lors de trois concours de subventions de projet consécutifs ou plus; une distinction attribuée à seulement 1% des évaluateurs et évaluatrices au pays. David Knapp a pour sa part obtenu trois mentions de contribution exceptionnelle. Cette reconnaissance témoigne de la qualité remarquable de leur travail d’évaluation et de leur participation constructive aux discussions des comités.
![]()
-
29 juillet 2025 Les antigènes tumoraux non mutés : des cibles exploitables pour l’immunothérapie
L’équipe de Claude Perreault, directeur de l’Unité de recherche en immunobiologie de l’IRIC, a identifié de nouveaux antigènes tumoraux qui pourraient mener au développement de vaccins pour le traitement de deux cancers : le mélanome et le cancer du poumon non à petites cellules. Pour y arriver, l’équipe menée par la doctorante Anca Apavaloaei a adopté une approche non biaisée qui examine l’ensemble du matériel génétique, y compris l’ADN qualifié de « poubelle » parce qu’il ne code pour aucune protéine connue. Le travail, fruit de collaborations avec la compagnie Epitopea, l’Université McGill, l’Université de Liège et l’Université de Lausanne, fait l’objet d’une publication dans le journal Nature Cancer.
![]()
-
22 juillet 2025 Julie Lessard et David Knapp sont récipiendaires du plus récent concours des IRSC
Les Instituts de recherche en santé du Canada (IRSC) ont récemment attribué les subventions du programme Projet pour le concours du printemps 2025. Ce programme vise à soutenir les idées originales ayant le potentiel de faire avancer les connaissances fondamentales et appliquées en santé. Un projet impliquant des équipes de l’IRIC est récipiendaire de ces prestigieux octrois.
![]()
-
22 juillet 2025 La course à pied : un miroir de la vie. Témoignage de Sasmita Tripathy, directrice adjointe à l’Unité de découverte de médicaments de l’IRIC
Sasmita Tripathy pratique la course à pied depuis plusieurs années; un sport qu’elle affectionne pour son bien-être, à la fois physique et psychologique. À travers son témoignage, elle nous présente comment toutes les sphères de sa vie sont interreliées; une réflexion touchante qui met de l’avant sa détermination, sa bonté et sa volonté de changer les choses, au laboratoire comme dans sa vie personnelle. L’IRIC est fier de vous présenter cette personnalité inspirante.
![]()
-
10 juillet 2025 De nouveaux outils génétiques pour étudier le remodelage de la chromatine dans l’hématopoïèse
L’équipe de Julie Lessard, directrice de l’Unité de recherche sur la structure de la chromatine et la biologie des cellules souches de l’IRIC, a généré de nouveaux outils génétiques pour étudier le rôle de deux sous-unités des complexes de remodelage de la chromatine SWI/SNF dans l’hématopoïèse. Le travail, mené par le conseiller à la recherche Pierre Priam, fait l’objet d’une publication dans le journal Experimental Hematology.
![]()
-
9 juillet 2025 Concours de recrutement étudiant 2025 : à la rencontre d’une relève scientifique inspirante!
Le Concours de recrutement étudiant de l’IRIC offre chaque année aux étudiantes et étudiants intéressés à mener des études supérieures en recherche sur le cancer une opportunité unique de participer à un événement de recrutement international à Institut de recherche en immunologie et en cancérologie de l’Université de Montréal.
![]()
-
7 juillet 2025 Le Réseau de Cellules Souches finance deux projets de l’équipe de Guy Sauvageau
Le Réseau de Cellules Souches (RCS) a récemment accordé 13,5 M$ pour financer 36 projets de recherche et essais cliniques en médecine régénératrice au pays. Guy Sauvageau, directeur de l’Unité de recherche en génétique moléculaire des cellules souches, obtient du financement pour deux projets via ces octrois.
![]()
-
4 juillet 2025 Cinq bourses et subventions des Fonds de recherche du Québec octroyées à des membres de l’IRIC pour l’année 2025-2026.
Les Fonds de recherche du Québec (FRQ) offrent pour l’année 2025-2026 un montant de 38,2 M$ en bourses de formation, 13,6 M$ en bourses de carrière et 10,8 M$ en subventions de recherche, pour un total de 62,6 M$ en nouveaux octrois pour l’année 2025-2026.
![]()
-
2 juillet 2025 Un financement de 6,5 M$ pour comprendre et cibler la dormance des cellules cancéreuses ovariennes
La Société canadienne du cancer (SCC) a récemment fait l’annonce des résultats du concours 2025 des Subventions d’Équipe Découverte : Transformer l’avenir du cancer métastatique. Philippe Roux, directeur scientifique et directeur de l’Unité de recherche en signalisation cellulaire et protéomique de l’IRIC, fait partie d’une équipe multidisciplinaire et multi-centres récipiendaire d’un financement de 6,5 M$ qui permettra de comprendre et cibler la dormance du cancer de l’ovaire.
![]()
-
25 juin 2025 La relève étudiante mise à l’honneur lors de la 11e journée scientifique de l’IRIC!
La 11e journée scientifique, tenue le 12 juin dernier, a permis de mettre en lumière le travail de la communauté scientifique de l’IRIC. Près de 190 personnes étaient présentes et ont eu l’occasion d’assister à neuf présentations orales, six présentations éclaires, et 50 présentations par affiche. Afin de souligner le savoir de la relève scientifique, sept prix de présentations par affiche et deux prix de présentations orales ont été remis.
![]()
-
13 juin 2025 Succès pour l’IRIC au Festival Eurêka! 2025
Le 30 mai dernier, en direct de l’île Sainte-Hélène, l’lRIC a pris part à la 18e édition du festival Eurêka! Ce festival est l’occasion pour les familles et les jeunes de la relève de plonger dans l’univers de la découverte scientifique.
![]()
-
10 juin 2025 Un Coup de cœur pour Éric Bonneil dans le cadre des Prix du recteur 2025 de l’Université de Montréal
Les Prix du recteur 2025 de l’Université de Montréal ont été remis le 29 mai dernier pour souligner les contributions remarquables de membres du personnel dont l’engagement et les réalisations incarnent de façon exemplaire les valeurs de l’Université. C’est avec grande fierté que l’IRIC souligne la distinction d’Éric Bonneil, responsable de la plateforme de protéomique de l’Institut, comme Coup de cœur dans la catégorie Innovation.
![]()
-
4 juin 2025 À la rencontre de Doris Alexandra Schuetz, Conseillère principale de recherche à l’Unité de découverte de médicaments
Doris Alexandra Schuetz est une source d’inspiration pour plusieurs membres de la communauté de l’IRIC. Professionnelle engagée et dédiée au quotidien dans la lutte contre le cancer, Doris se surpasse également dans la course à pied, un sport qu’elle pratique depuis quelques années maintenant. Désireuse de joindre l’utile à l’agréable, Doris a amassé, depuis 2022, près de 5000$ pour la recherche contre le cancer à l’IRIC, via sa participation au Marathon Beneva de Montréal. L’IRIC est fier de vous présenter cette personnalité inspirante.
![]()
-
29 mai 2025 L’évasion de mutants BRAF stoppée par des « agents » thérapeutiques
L’équipe de Marc Therrien, directeur général et directeur de l’Unité de recherche en signalisation intracellulaire de l’IRIC, a identifié des changements structurels majeurs qui permettent à la protéine BRAF d’échapper aux contrôles et de mimer son activation, ce qui lui confère un fort potentiel oncogénique. De plus, les chercheurs et chercheuses ont réussi à rétablir complètement l’état conformationnel normal de la protéine par l’utilisation de petites molécules – ce qui constitue une première. L’étude, publiée dans la prestigieuse revue Science, est le fruit du travail conjoint de Hugo Lavoie (directeur adjoint), Ting Jin (conseillère à la recherche) et Driss Lajoie (conseiller à la recherche), qui en sont les co-premiers auteurs. Elle s’inscrit dans une collaboration étroite entre plusieurs équipes de recherche qui, en plus du laboratoire Therrien, impliquent des équipes de la NYU Langone (New York), de l’Université de Bordeaux et de l’Université de Calgary.
![]()
-
23 mai 2025 Les récipiendaires du concours IRIC scientifiques de demain 2025 arrivent à l’Institut
Cet été, 10 étudiantes et étudiants ont l’opportunité de compléter un stage de recherche de 12 ou de 16 semaines à l’IRIC, en plus de bénéficier d’une bourse d’excellence.
![]()
-
21 mai 2025 Pavillons Jean-Coutu et Marcelle-Coutu : il y a 20 ans un rêve se réalisait
Le 26 avril 2005 avait lieu l’inauguration des deux pavillons pour y loger respectivement la Faculté de pharmacie et l’Institut de recherche en immunologie et en cancérologie (IRIC) de l’Université de Montréal.
![]()
-
30 avril 2025 Une enveloppe totale de 612 610 $ pour un projet dirigé par Sylvain Meloche, avec le soutien de l’IRIC, d’IRICoR, d’Immune Biosolutions et de la SRC
Le ministère de l’Économie, de l’Innovation et de l’Énergie (MEIE) du Québec a octroyé en début d’année 2025 un financement de 475,000$ à l’équipe de Sylvain Meloche, qui dirige l’Unité de recherche en signalisation et croissance cellulaire de l’IRIC. Axelys a soutenu l’équipe dans le cadre du montage de cette demande de financement au titre du Programme de Maturation technologique (PSOv2d). Ce financement vient agir en effet de levier aux soutiens privés additionnels apportés respectivement par Immune Biosolutions et la Société de Recherche sur le Cancer (SRC).
![]()
-
15 avril 2025 Gala Audace de l’IRIC : 1 060 025$ amassés pour la recherche en cancérologie
Le 9 avril dernier avait lieu l’édition 2025 du Gala Audace de l’Institut de recherche en immunologie et en cancérologie (IRIC) de l’Université de Montréal. Grâce à la générosité de plus de 300 convives rassemblées au Marché Bonsecours, de nos précieux donateurs et donatrices, et de nos commanditaires, un montant de 1 060 025$ a été amassé pour soutenir la recherche en cancérologie au sein de l’IRIC.
![]()
-
26 mars 2025 Manipuler le très petit à grande échelle
L’équipe de Delphine Bouilly, directrice de l’Unité de recherche en conception et application de nanobiocapteurs électroniques de l’IRIC, a développé une technique originale pour manipuler et déplacer le graphène, un matériau d’un atome d’épaisseur impliqué dans l’assemblage de puces électroniques, pour des applications en diagnostic moléculaire. Menée par l’étudiante au doctorat Amira Bencherif, l’étude a été publiée dans le journal npj 2D materials and applications.
![]()
-
3 mars 2025 Rencontrez Carino Gurjao, nouveau chercheur à l’IRIC
L’IRIC est fier de souligner l’arrivée de Carino Gurjao comme nouveau chercheur principal à l’Unité de recherche en médecine génomique et intégrative.
Le professeur Gurjao a accepté avec générosité de répondre à quelques questions :
![]()
-
3 mars 2025 L’IRIC et l’UdeM recrutent Carino Gurjao à titre de chercheur principal
L’IRIC est fier de souligner l’arrivée de Carino Gurjao comme nouveau chercheur principal à l’Unité de recherche en médecine génomique et intégrative. Celui-ci occupera le poste de professeur adjoint au Département de médecine de l’Université de Montréal (UdeM) affilié à IVADO.
![]()
-
19 février 2025 Célébration de 20 ans de greffe pour William Brock!
Le 17 février 2025 restera une journée marquante pour William Brock, président du conseil d’administration de l’IRIC. Vingt années se sont écoulées depuis qu’il a reçu une greffe de cellules souches lui ayant permis de guérir d’une leucémie… une greffe qui a changé sa vie à tout jamais!
![]()
-
14 février 2025 Les Instituts de recherche en santé du Canada financent cinq projets de recherche menés à l’IRIC
Les Instituts de recherche en santé du Canada (IRSC) ont récemment attribué les subventions du programme Projet pour le concours de l’automne 2024. Ce programme vise à soutenir les idées originales ayant le potentiel de faire avancer les connaissances fondamentales et appliquées en santé.
Au pays, ce sont 453 projets de recherche, représentant un investissement total de 411 millions de dollars, qui ont été financés. Cinq projets impliquant des équipes de l’IRIC sont récipiendaires de ces prestigieux octrois.
![]()
-
11 février 2025 Une étudiante engagée à valoriser la représentation des femmes et filles de science!
En cette Journée internationale des femmes et des filles de science, l’IRIC a eu la chance de s’entretenir avec Fanny-Meï Cloarec-Ung, étudiante au doctorat dans le laboratoire de David Knapp. Engagée à améliorer la représentation des femmes dans le domaine des sciences, Fanny-Meï se démarque quant à son leadership et à sa volonté de faire une réelle différence.
![]()
-
28 janvier 2025 Ludovic Tamaro : parcours d’un jeune patient sauvé grâce à la recherche
En cette Journée mondiale contre le cancer, rencontrez Ludovic Tamaro, un jeune de 24 ans ayant reçu un diagnostic de leucémie myéloïde aiguë et de myélodysplasie à l’âge de sa majorité.
![]()
-
23 janvier 2025 Une image vaut mille mots – ou pourquoi la technologie de peinture cellulaire est prometteuse pour la découverte de médicaments
La plateforme de criblage à haut débit de l’IRIC obtient 583 654 $ du ministère de l’Économie, de l’Innovation et de l’Énergie du Québec à la suite d’un appel à projets lancé dans le cadre de la Stratégie québécoise de recherche et d’investissements en innovation 2022-2027 (SQRI2). Le projet financé vise l’intégration d’une technologie de peinture cellulaire en temps réel et de classification phénotypique par intelligence artificielle pour la découverte de nouveaux médicaments.
![]()
-
22 janvier 2025 Sébastien Lemieux prend la direction scientifique de Calcul Québec
Sébastien Lemieux, directeur de l’Unité de recherche en bio-informatique fonctionnelle et structurale de l’IRIC, a été nommé directeur scientifique de Calcul Québec en novembre dernier.
![]()
-
15 janvier 2025 Identification de petites molécules prometteuses pour le traitement de cancers pédiatriques
L’équipe de Brian Wilhelm, directeur de l’Unité de recherche en génomique à haut débit de l’IRIC, a mis au point une nouvelle plateforme de découverte de médicaments pour les leucémies à haut risque. C’est la doctorante Safia Safa-Tahar-Henni qui a mené le projet, objet d’une publication dans le journal Leukemia.
![]()
-
9 janvier 2025 Le programme Recherche Ton Impact de Millénium Québécor récompense la doctorante Madline Sauvage pour son entreprise en démarrage.
Madline Sauvage, étudiante au doctorat dans les laboratoires de Delphine Bouilly et Sylvie Mader à l’IRIC, a obtenu une bourse de 6000 $ à l’issue du parcours entrepreneurial Recherche ton Impact du programme Millénium Québécor de l’Université de Montréal.
![]()
-
7 janvier 2025 Un financement majeur pour la création d’immunothérapies pour les laboratoires de Claude Perreault et de Pierre Thibault
Grâce à une subvention majeure de près de 1,5 M$ du gouvernement du Québec, le CQDM et la compagnie Epitopea sont en mesure de financer un projet de recherche collaboratif à haut potentiel au cœur de l’Université de Montréal, impliquant directement les équipes de recherche de Claude Perreault et de Pierre Thibault, chercheurs principaux à l’IRIC. L’objectif du projet est de développer une nouvelle immunothérapie pour traiter efficacement les patientes et patients atteints de cancers du poumon et de l’ovaire.
![]()
-
16 décembre 2024 Le laboratoire du Dr Vincent Quoc-Huy Trinh obtient un financement important
À l’issue du concours du Fonds des leaders John-R.-Evans, de la Fondation canadienne pour l’innovation, et du programme de soutien à la recherche du ministère de l’Économie, de l’Innovation et de l’Énergie du Québec, le laboratoire de Dr Vincent Quoc-Huy Trinh obtient un financement important pour son projet de recherche prometteur : « L’effet des fibroblastes sur la transformation maligne des cellules souches dysplasiques dans les tumeurs pancréatiques », et ce, pour la période 2024-2026.
![]()
-
9 décembre 2024 Un consortium multinational dirigé par Julie Lessard bénéficie d’une subvention majeure
Dans le cadre de l’appel transnational conjoint 2023 de TRANSCAN-3 sur la recherche translationnelle en épigénétique du cancer, Julie Lessard s’est vu accorder une subvention de 2,03 M$ pour le consortium multinational dont elle assure la direction, aux côtés de cinq collègues en provenance de la France, de l’Espagne et d’Israël.
![]()
-
20 novembre 2024 Deux réponses physiologiques pour protéger les tissus des défauts nucléaires
Une nouvelle étude par l’Unité de recherche sur la régulation du cycle cellulaire, dirigée par Vincent Archambault, identifie deux réponses physiologiques activées lorsque des défauts de reformation nucléaire sont détectées par les cellules à l’issue de leur division. Ces réponses joueraient un rôle crucial pour protéger l’intégrité des tissus pendant leur développement. Faisant l’objet d’une publication dans le journal PLOS Biology, le projet a été mené par la doctorante Jingjing Li.
![]()
-
18 novembre 2024 Ensemble pour la cause!
Les 21 et 22 septembre dernier avait lieu le Marathon Beneva de Montréal et l’IRIC est fier d’annoncer que près de 33 500$ ont été amassés, totalisant 454 dons. Cette collecte substantielle a permis à l’IRIC de se positionner au 5e rang de tous les organismes participants.
![]()
-
12 novembre 2024 Subventions majeures pour la recherche à l’IRIC
C’est avec grand plaisir que l’IRIC souligne les récipiendaires de subventions majeures offertes par des organismes partenaires. Une reconnaissance amplement méritée pour les équipes de recherche de l’Institut qui ont certainement le vent dans les voiles!
![]()
-
6 novembre 2024 Annonce des récipiendaires du concours Science Réflexion 2024
L’IRIC a le plaisir de vous annoncer les gagnants et gagnantes du concours Science Réflexion 2024. Ce concours annuel met en lumière la créativité et le talent de la communauté de l’IRIC et présente la science sous un autre angle.
![]()
-
6 novembre 2024 Défi : créer une académie en matériaux de pointe
Delphine Bouilly, représentante de l’Université de Montréal sur l’exécutif du Regroupement québécois sur les matériaux de pointe (RQMP), et ses collègues mettront sur pied l’Académie des Matériaux Avancés (AMA), une nouvelle initiative pour enrichir la formation aux cycles supérieurs dans le domaine des matériaux de pointe. Le projet est rendu possible par l’obtention d’une subvention de 1,65M $ du programme FONCER (Formation orientée vers la nouveauté, la collaboration et l’expérience en recherche) du Conseil de recherches en sciences naturelles et en génie du Canada (CRSNG).
![]()
-
21 octobre 2024 Une lauréate des Bourses de recherche au doctorat de la SRC à l’IRIC!
L’IRIC tient à féliciter Anaïs Vivet pour l’obtention de la Bourse de recherche au doctorat de la Société de recherche sur le cancer (SRC).
![]()
-
16 octobre 2024 Améliorer la conception des expériences impliquant des biosenseurs BRET pour les rendre plus pertinentes physiologiquement
Une nouvelle étude par le laboratoire de Michel Bouvier, directeur de l’Unité de recherche en pharmacologie moléculaire de l’IRIC, compare les avantages et inconvénients de divers biosenseurs utilisés pour analyser la signalisation des récepteurs couplés aux protéines G. Le projet de recherche a été mené conjointement par le postdoctorant Shane Wright, la conseillère à la recherche Charlotte Avet et la postdoctorante Supriya Gaitonde. Il fait l’objet d’une publication dans le journal Science Signaling.
![]()
-
3 octobre 2024 Anca Apavaloaei reçoit un Prix de la meilleure thèse 2024
Anca Apavaloaei, doctorante dans le laboratoire de Claude Perrault, a reçu le Prix de la meilleure thèse 2024 dans la catégorie Sciences de la santé. Décernés par les Études supérieures et postdoctorales (ESP) de l’Université de Montréal, ces prix récompensent des travaux doctoraux remarquables.
![]()
-
2 octobre 2024 Deux étudiants décidés à marcher pour la leucémie
La marche Illumine la nuit, orchestrée chaque année par la Société de leucémie et lymphome du Canada, réunit la communauté des cancers du sang partout au pays. L’événement permet d’amasser des fonds pour la recherche sur les 137 types de cancers du sang. Les étudiants Ryan Borotra et Tyler Lussier ont mobilisé une équipe pour l’IRIC et soutiendront la cause lors du volet montréalais d’Illumine la nuit, le 26 octobre prochain. Rencontre avec ces deux représentants d’une relève engagée.
![]()
-
18 septembre 2024 Développement d’un outil pour l’étude de nouveaux traitements du cancer du foie
L’équipe de Sylvain Meloche, directeur de l’Unité de recherche en signalisation et croissance cellulaire de l’IRIC, a concu un nouveau modèle préclinique pour l’étude du plus fréquent sous-type de cancer du foie. Publié dans le journal Disease Models & Mechanisms, le travail a été mené conjointement par l’associée de recherche Laure Voisin et la conseillère à la recherche Marjorie Lapouge. Le chercheur Vincent Trinh, directeur de l’Unité de recherche en histologie digitale et pathologie avancée de l’IRIC, a également contribué à l’étude.
![]()
-
10 septembre 2024 Katherine Borden élue membre à l’Académie canadienne des sciences de la santé
Katherine Borden, chercheuse principale et directrice de l’Unité de recherche en structure et fonction du noyau cellulaire à l’IRIC, et professeure titulaire au Département de pathologie et biologie cellulaire à la Faculté de médecine de l’Université de Montréal, fait partie des XX nouveaux membres élus à l’Académie canadienne des sciences de la santé (ACSS).
![]()
-
9 septembre 2024 L’IRIC repart sur la route cet automne
Dans le cadre de sa tournée de recrutement étudiant IRIC sur la route, l’équipe des affaires académiques de l’Institut participera cet automne à plusieurs salons d’études supérieures organisés par des universités canadiennes.
![]()
-
4 septembre 2024 Des parasites génétiques impliqués dans le développement et la fonction du système immunitaire?
Une récente étude réalisée par l’équipe de Claude Perreault, directeur de l’Unité de recherche en immunobiologie de l’IRIC, propose trois fonctions potentielles pour des séquences d’ADN dites « parasites » dans le développement des lymphocytes T. Mené par le doctorant Jean-David Larouche, le travail fait l’objet d’une publication dans le journal eLife.
![]()
-
31 juillet 2024 Une approche inédite pour étudier l’hypoxie permet l’identification d’un nouveau marqueur potentiel pour les cancers ovariens
Dans une nouvelle étude, l’équipe d’Etienne Gagnon, directeur de l’Unité de recherche en immunobiologie du cancer de l’IRIC, a développé un protocole de culture cellulaire reproduisant fidèlement les conditions caractéristiques des tumeurs primaires. Le groupe a également identifié une nouvelle forme de la protéine WT1 associée à une faible survie à long terme pour les personnes atteintes de cancers de l’ovaire. Parue dans le journal Cancer Gene Therapy, l’étude a été menée par le doctorant Jordan Quenneville.
![]()
-
30 juillet 2024 Un leadership tout sauf nanométrique pour Delphine Bouilly
Delphine Bouilly, directrice de l’Unité de recherche en conception et application de nanobiocapteurs électroniques de l’IRIC, récolte les bons coups depuis quelques mois. Nommée à la tête de trois réseaux stratégiques, elle a également vu sa Chaire de recherche du Canada en bionanoélectronique être renouvelée et obtenu un prix prestigieux de l’Electrochemical Society. Retour sur son parcours et ses accomplissements.
![]()
-
29 juillet 2024 Trois finissantes et finissants de l’IRIC sur la liste d’honneur du Recteur de l’Université de Montréal
L’IRIC est fier de compter trois de ses finissants et finissantes parmi les plus récentes nominations à la liste d’honneur du Recteur.
![]()
-
25 juillet 2024 Sébastien Carréno collabore avec une équipe française sur une étude publiée dans EMBO J
Sébastien Carréno, directeur de l’Unité de recherche sur les mécanismes de la morphogénèse cellulaire au cours de la mitose et de la migration de l’IRIC, signe une nouvelle publication parue dans EMBO J avec des collègues de l’Institut de pharmacologie et biologie structurale de Toulouse. Le projet a été mené par l’étudiante au doctorat Perrine Verdys, co-supervisée par le professeur Carréno. Les travaux du groupe démontrent que les macrophages, des cellules immunitaires, peuvent migrer sans les protéines ERM, des protéines du cortex cellulaire jusqu’alors considérées essentielles à tout processus de migration cellulaire.
![]()
-
23 juillet 2024 Trois projets menés à l’IRIC financés par les Instituts de recherche en santé du Canada
Les Instituts de recherche en santé du Canada (IRSC) ont récemment attribué les subventions du programme Projet pour le concours du printemps 2024. Ce programme vise à soutenir les idées originales ayant le potentiel de faire avancer les connaissances fondamentales et appliquées en santé. Au pays, ce sont 373 projets de recherche, représentant un investissement total de 325 millions de dollars, qui ont été financés. Trois projets de l’IRIC sont récipiendaires de ces prestigieux octrois.
![]()
-
4 juillet 2024 Concours de recrutement étudiant 2024 : à la rencontre d’une relève motivée et diversifiée
L’édition 2024 s’est déroulée du 5 au 7 juin et a accueilli 32 participants et participantes provenant d’universités à travers le monde. Plus de 150 entrevues ont été planifiées cette année entre les participants et participantes et les chercheuses et chercheurs de l’Institut présents à l’événement.
![]()
-
25 juin 2024 Cibler la surface des cellules leucémiques par des immunothérapies
Les immunothérapies, des approches plus naturelles et moins toxiques que les chimiothérapies, ont connu des avancées majeures dans les dernières années. Elles demeurent toutefois peu exploitées dans le traitement des leucémies myéloïdes aiguës (LMA), un type de leucémies particulièrement hétérogènes génétiquement et difficiles à traiter. Le groupe Leucégène, dirigé par Guy Sauvageau (Unité de recherche en génétique moléculaire des cellules souches de l’IRIC) et Josée Hébert (Centre de recherche de l’Hôpital Maisonneuve-Rosemont), et impliquant les équipes de Philippe Roux, Sébastien Lemieux et Pierre Thibault à l’IRIC, ainsi que de Vincent-Philippe Lavallée au Centre de recherche du CHU Ste-Justine, a développé une nouvelle approche pour analyser les molécules présentes à la surface des cellules leucémiques. Leur travail a permis d’identifier, dans des spécimens de LMA, de nouvelles cibles à fort potentiel pour des immunothérapies. L’étude a été menée par Marie-Ève Bordeleau, directrice adjointe du laboratoire Sauvageau, et fait l’objet d’une publication dans le journal Cell Reports.
![]()
-
13 juin 2024 Marc Therrien assure l’intérim au poste de directeur général de l’IRIC
L’IRIC se réjouit d’annoncer la nomination du professeur Marc Therrien à titre de directeur général par intérim de l’IRIC. Le Comité exécutif de l’Université de Montréal a récemment entériné la recommandation formulée par le conseil d’administration de l’IRIC. Marc Therrien est chercheur principal à l’Unité de recherche en signalisation intracellulaire à l’Institut et professeur titulaire au Département de pathologie et biologie cellulaire de la Faculté de médecine de l’Université de Montréal.
![]()
-
6 juin 2024 Des bourses de la Fondation Cole pour deux étudiants de l’IRIC
Deux étudiants de l’IRIC se méritent une bourse doctorale de la Fondation Cole d’une valeur de 50 000 $ pour deux ans.
![]()
-
5 juin 2024 Bienvenue aux récipiendaires des bourses IRIC scientifiques de demain 2024!
Ce concours de bourses permet à des étudiants et étudiantes de premier cycle de venir effectuer un stage de recherche de 12 à 16 semaines à l’IRIC pendant le trimestre d’été.
![]()
-
5 juin 2024 Bourses de maîtrise et de doctorat de l’IRIC – Récipiendaires du Concours Hiver 2024
L’objectif du Concours Bourses de maîtrise et de doctorat de l’IRIC est d’appuyer les étudiantes et étudiants de l’IRIC qui ont un excellent dossier académique et de recherche, mais qui ne bénéficient pas de bourse nominale majeure.
![]()
-
5 juin 2024 Succès pour l’IRIC au Festival Eurêka! 2024
Le 24 mai dernier, en direct de l’île Sainte-Hélène, l’lRIC a pris part à la 17e édition du festival Eurêka! Ce festival est l’occasion pour les familles et les jeunes de la relève de plonger dans l’univers de la découverte scientifique.
![]()
-
4 juin 2024 Entre le laboratoire et la scène, Vanessa Laflamme cumule les kilomètres et les dollars en soutien à la recherche
Biologiste de formation, ayant notamment complété une maîtrise en biologie moléculaire à l’IRIC, Vanessa travaille quelques années en industrie biotechnologique avant de revenir à l’IRIC en 2020. Elle y œuvre depuis à titre de conseillère à la recherche au sein de l’Unité de découverte de médicaments dirigée par Anne Marinier. Membre de l’Équipe IRIC pour une seconde année, elle a généreusement accepté de nous partager ses expériences de course à pied et de collecte de fonds.
![]()
-
30 mai 2024 Fin de mandat de Michel Bouvier en tant que directeur général à l’IRIC
L’IRIC souligne la fin de mandat deMichel Bouvier, en tant que directeur général de l’Institut depuis 2014.
![]()
-
13 mai 2024 Dix-sept bourses et subventions des Fonds de recherche du Québec octroyées à des membres de l’IRIC pour l’année 2023-2024
Les Fonds de recherche du Québec (FRQ) offrent 53,2 M$ en bourses de formation, 13,7 M$ en bourses de carrière et 52,8 M$ en subventions de recherche pour un total de 119,7 M$ en nouveaux octrois pour l’année 2024-2025. L’IRIC est fier de compter plusieurs de ses membres parmi les lauréats et lauréates de ces concours.
![]()
-
10 mai 2024 Les Grandes Retrouvailles à l’IRIC : découvrir l’univers de la recherche fondamentale
Dans le cadre des Grandes Retrouvailles de l’Université de Montréal, l’IRIC ouvrait ses portes au grand public le 9 mai dernier pour lui permettre de découvrir l’univers de la recherche fondamentale. Pour l’occasion, plus d’une vingtaine de personnes étaient présentes pour apprendre sur la cancérologie et découvrir l’Institut.
![]()
-
9 mai 2024 Un financement de 3,7M$ pour un projet de recherche sur le rajeunissement cellulaire
Un projet de recherche collaboratif entre les équipes de Guy Sauvageau, directeur de l’Unité de recherche en génétique moléculaire des cellules souches de l’IRIC, et d’Anne Marinier, directrice générale de la société biotechnologique RejuvenRx, a récemment obtenu un financement de 3 697 199 $. Cet octroi est rendu possible par les investissements du Consortium québécois sur la découverte du médicament (CQDM), du gouvernement du Québec, de RejuvenRx, des Instituts de recherche en santé du Canada et du fonds Partenariat de l’Université de Montréal.
![]()
-
6 mai 2024 Un financement de 21 M $ pour contrer la résistance aux médicaments antimicrobiens
Les Fonds de recherche biomédicale du Canada (FRBC) et Fonds d’infrastructure et de recherche en sciences biologiques (FIRSB) investissent 21 M $ dans un projet de recherche qui vise à accélérer la découverte de nouveaux antibiotiques pour contrer les bactéries résistantes aux médicaments. Dirigé par Yves Brun, professeur au département de microbiologie, infectiologie et immunologie et chercheur au Centre d’innovation biomédicale à la Faculté de médecine de l’UdeM, le projet impliquera différentes équipes de l’IRIC.
![]()
-
11 avril 2024 750 000$ amassés lors du Gala Audace de l’IRIC de l’Université de Montréal
Le 10 avril dernier, plus de 250 convives se sont réunis pour le Gala Audace 2024 de l’IRIC. Grâce à la générosité des donateur(rice)s et des invité(e)s, un montant de 750 00 $ a été amassé. Depuis 2014, ce sont plus de 8 millions de dollars qui ont été récoltés à l’occasion du Gala Audace, permettant de pérenniser la recherche fondamentale réalisée à l’IRIC et de perfectionner les thérapies contre le cancer.
![]()
-
2 avril 2024 Succès pour la soirée de vulgarisation scientifique Cancer et immunologie!
Le 28 mars dernier, quatre étudiantes de l’IRIC se sont prêtées au jeu de vulgariser la science lors de l’événement BistroBrain : Cancer et immunologie.
![]()
-
25 mars 2024 Une nouvelle stratégie basée sur la surdose de cuivre pour traiter la LMA
Malgré les avancées thérapeutiques des dernières années dans le traitement de la leucémie myéloïde aiguë (LMA), cette pathologie reste associée à un mauvais pronostic. Dans une nouvelle étude, le groupe Leucegene dirigé par Guy Sauvageau, directeur de l’Unité de recherche en génétique moléculaire des cellules souches de l’IRIC, Anne Marinier, directrice de l’Unité de découverte du médicament de l’IRIC, et Josée Hébert (Banque de cellules leucémiques du Québec (BCLQ), Centre de recherche de l’Hôpital Maisonneuve-Rosemont) propose une stratégie thérapeutique basée sur la surdose de cuivre comme traitement d’un sous-groupe génétique de LMA particulièrement sensible à cette approche. Mené par Céline Moison et Deanne Gracias pour la biologie, et Julie Schmitt et Réjean Ruel pour la chimie, en collaboration avec l’équipe du laboratoire de génétique de la BCLQ, ce projet fait l’objet d’une publication dans le prestigieux journal Science Advances.
![]()
-
21 mars 2024 Des honneurs de la SCBM pour Sylvie Mader et Guy Sauvageau
L’IRIC félicite Sylvie Mader et Guy Sauvageau, récipiendaires de prix de Société canadienne pour les biosciences moléculaires (SCBM). Sylvie Mader, directrice de l’Unité de recherche en ciblage moléculaire dans le traitement du cancer du sein de l’IRIC, est la lauréate 2024 du Prix de conférence d’honneur Jeanne Manery-Fisher. Guy Sauvageau, directeur de l’Unité de recherche en génétique moléculaire des cellules souches, est quant à lui récipiendaire de la médaille d’or Arthur-Wynne.
![]()
-
5 mars 2024 Identification d’une activité enzymatique requise pour la complétion de la division cellulaire
La division cellulaire, processus requis pour la survie de toutes les espèces, permet de séparer le matériel génétique d’une cellule mère et de le partager entre ses deux cellules filles. Plusieurs aspects de la division cellulaire demeurant mal compris à ce jour, l’équipe de Jean-Claude Labbé, directeur de l’Unité de recherche en division et différenciation cellulaire, s’est penchée sur l’une de ses dernières étapes, la cytocinèse. L’équipe a identifié une nouvelle protéine, OSGN-1, comme étant requise pour la complétion correcte de la division cellulaire. L’étude, publiée dans le journal PNAS, a été menée par l’associée de recherche Eugénie Goupil et l’étudiante au doctorat Léa Lacroix.
![]()
-
20 février 2024 L’IRIC souligne la Journée internationale des femmes et filles de science
Le 10 février dernier, l’IRIC était présent au Centre des sciences de Montréal pour la journée Femmes et filles de Science à l’occasion de la Journée internationale des femmes et des filles de science. Cette 7e édition de l’événement a attiré une foule record, avec plus de 3300 curieux et curieuses au rendez-vous pour découvrir différentes disciplines scientifiques.
![]()
-
5 février 2024 Pasquale Gentile: « Sans la science, je n’aurais pas survécu à mon cancer. »
Dans la foulée du 4 février, Journée mondiale contre le cancer, visionnez le témoignage de Pasquale Gentile, un patient ayant reçu la thérapie cellulaire UM171.
![]()
-
1er février 2024 La Société canadienne du cancer octroie une subvention à Geneviève Deblois
Geneviève Deblois, directrice de l’Unité de recherche sur les mécanismes épigénétiques et métabolisme du cancer de l’IRIC, est récipiendaire d’une Subvention de recherche pour chercheuses et chercheurs prometteurs de la Société canadienne du cancer (SCC). Lors du concours 2023, seize de ces subventions ont été accordées au pays pour faire progresser les programmes de recherche en cancérologie. Seule chercheuse financée au Québec, Geneviève Deblois obtient un financement de 550 000 $ pour son projet « Trouver de meilleures façons de traiter le cancer du sein triple négatif ».
![]()
-
29 janvier 2024 Expansion des cellules souches hématopoïétiques : le mécanisme d’action de la molécule UM171 implique une régulation de la protéine MYC
L’expansion ex vivo de cellules souches hématopoïétiques (CSH), une avancée importante pour les thérapies cellulaires, peut entraîner des stress réplicatifs et métaboliques; un peu comme le fait le vieillissement. Dans ses efforts pour identifier les meilleures stratégies d’expansion des CSH, l’équipe de Guy Sauvageau, directeur de l’Unité de recherche en génétique moléculaire des cellules souches de l’IRIC, s’est penchée sur les mécanismes moléculaires induits pas la molécule UM171. Celle-ci, découverte conjointement en 2014 par son laboratoire et celui de Anne Marinier, directrice de l’Unité de découverte de médicaments de l’IRIC, permet l’expansion ex vivo des CSH dérivées du sang de cordon ombilical. Leur plus récente étude, menée par la chercheuse Jalila Chagraoui et publiée dans le journal Blood, rapporte que la molécule UM171 préserve les CSH du stress induit par la culture cellulaire en modulant l’activité de la protéine MYC.
![]()
-
25 janvier 2024 Décoder les bases moléculaires et structurales de la transduction de signaux pour concevoir des médicaments plus performants
Les récepteurs couplés aux protéines G (RCPG) sont liés par une panoplie de ligands : plus de 500 molécules présentes naturellement chez l’humain (comme les hormones) ainsi que le tiers des médicaments approuvés les ciblent. La liaison de ces ligands aux RCPG entraîne l’activation sélective de différentes voies de signalisation, qui sont impliquées dans des processus aussi variés que le métabolisme, la croissance cellulaire et les réponses immunitaires. Michel Bouvier, directeur de l’Unité de recherche en pharmacologie moléculaire et directeur général de l’IRIC, et ses collaborateurs ont voulu mieux comprendre, à l’échelle atomique, les déterminants moléculaires et structuraux qui dictent la capacité d’un ligand à activer un RCPG. Le travail, une collaboration avec Madan Babu, chercheur au Ste-Jude Research Hospital, et Brian Kobilka, chercheur à Stanford University et co-lauréat du prix Nobel de chimie 2012, a été mené par Franziska Heidenreich alors qu’elle était postdoctorante dans le laboratoire Bouvier. Il fait l’objet d’une publication dans le journal Science.
![]()
-
23 janvier 2024 Une colle moléculaire qui favorise la dégradation de la cycline K
Les protéines CDK12 et cycline K forment un complexe jouant des rôles importants dans plusieurs types de cancers, notamment les mélanomes et les cancers du sein. L’équipe de Philippe Roux, directeur scientifique et directeur de l’Unité de recherche en signalisation cellulaire et protéomique de l’IRIC, a caractérisé le mode d’action d’un nouvel inhibiteur de CDK12, développé pour son potentiel thérapeutique anticancer. Les résultats obtenus révèlent que l’inhibiteur en question, la molécule SR-4835, agit comme colle moléculaire pour induire la dégradation de la cycline K et ainsi inactiver le complexe qu’elle forme avec CDK12. Mené conjointement par les postdoctorants Thibault Houles et Jonathan Boucher, le projet fait l’objet d’une publication dans le journal Cell Death Discovery.
![]()
-
15 janvier 2024 Retour sur le 20e anniversaire de l’IRIC : Une année de célébration!
Au cours de ses 20 dernières années, l’IRIC a bâti un modèle de recherche unique au pays et rassemblé des expertises exceptionnelles. Afin de mettre en lumière sa communauté, de faire rayonner la science et de mettre la table sur les réalisations à venir, l’Institut a créé une programmation spéciale qui s’est échelonnée sur l’année 2023. Voici, en rétrospective, les différentes initiatives et célébrations qui ont su marquer cette année spéciale.
![]()
-
10 janvier 2024 Une nouvelle étude identifie des cibles pour l’immunothérapie dans deux sous-types de cancer du sein
Le cancer du sein est le cancer le plus répandu dans le monde. Il se présente en plusieurs sous-types qui diffèrent d’un point de vue immunologique; certains génèrent des réponses immunitaires plus fortes que d’autres. L’équipe de Claude Perreault, directeur de l’Unité de recherche en immunobiologie de l’IRIC, a utilisé une approche de protéogénomique pour étudier l’immunopeptidome de deux sous-types de cancer du sein : les cancers du sein à récepteurs hormonaux positifs et les cancers du sein triples négatifs. Ils ont ainsi identifié plusieurs nouveaux antigènes pour chaque sous-type, lesquels se sont par ailleurs révélés capables de générer une réponse immunitaire in vitro. Ces nouveaux antigènes représentent donc des cibles potentielles pour l’immunothérapie anticancéreuse. Le projet a été mené par la doctorante Eralda Kina et fait l’objet d’une publication dans The Journal of Clinical Investigation.
![]()
-
20 décembre 2023 Un financement de 6M$ pour améliorer le traitement de la leucémie myéloblastique aiguë
Guy Sauvageau, à titre de directeur de l’Unité de recherche en génétique moléculaire des cellules souches de l’IRIC, et Anne Marinier, à titre de directrice générale de la société biotechnologique RejuvenRx, obtiennent 6M $ sur 3 ans de Génome Canada pour le projet « Mise au point d’un nouvel outil de dégradation de la cycline-K pour les patients atteints de LMA à haut risque et caractéristiques génomiques connexes ». Le financement est octroyé dans le cadre du Programme de partenariats pour les applications de la génomique de Génome Canada, qui vise à favoriser les partenariats entre l’industrie, des utilisateurs publics, et la recherche académique.
![]()
-
15 décembre 2023 Deux lauréates des Bourses de recherche au doctorat de la SRC à l’IRIC!
L’IRIC tient à féliciter Myriam Iliana Ibanez Rios et Karla Lucia Paez Martinez pour l’obtention de leur Bourse de recherche au doctorat de la Société de recherche sur le cancer (SRC). Elles comptent parmi les 21 récipiendaires de ces nouvelles bourses, qui offrent un financement de 70 000 $ sur deux ans. Cette nouvelle initiative de la SRC vise à apporter un soutien essentiel à la communauté doctorale.
![]()
-
14 décembre 2023 Deux récipendaires des bourses d’excellence de l’UdeM parmi notre communauté étudiante!
Le Vice-rectorat adjoint aux études supérieures et postdoctorales a souligné l’excellence étudiante par la remise de 155 bourses. Deux membres de l’IRIC comptent parmi les récipiendaires de ces bourses d’excellence. Les bourses sont octroyées en fonction de la qualité du dossier scolaire, de la persévérance et de l’engagement bénévole des candidats et candidates.
![]()
-
1er décembre 2023 Les piliers de l’IRIC : rencontrez Mélanie Fréchette
En 2023, l’IRIC fête ses 20 ans. Parmi les initiatives mises en place pour célébrer cet anniversaire, la série de portraits « Les piliers de l’IRIC » permettra de mettre en lumière les personnes qui ont contribué depuis les tous débuts, parfois dans l’ombre, à faire de l’IRIC ce qu’il est devenu.
Aujourd’hui, rencontrez Mélanie Fréchette, technicienne en santé animale pour le laboratoire de Guy Sauvageau.
![]()
-
1er décembre 2023 Les piliers de l’IRIC : rencontrez Sandra Weber
En 2023, l’IRIC fête ses 20 ans. Parmi les initiatives mises en place pour célébrer cet anniversaire, la série de portraits « Les piliers de l’IRIC » permettra de mettre en lumière les personnes qui ont contribué depuis les tous débuts, parfois dans l’ombre, à faire de l’IRIC ce qu’il est devenu.
Aujourd’hui, rencontrez Sandra Weber, conseillère à la recherche dans le laboratoire de Marc Therrien à l’IRIC.
![]()
-
27 novembre 2023 Les piliers de l’IRIC : rencontrez Jinny Émond
En 2023, l’IRIC fête ses 20 ans. Parmi les initiatives mises en place pour célébrer cet anniversaire, la série de portraits « Les piliers de l’IRIC » permettra de mettre en lumière les personnes qui ont contribué depuis les tous débuts, parfois dans l’ombre, à faire de l’IRIC ce qu’il est devenu.
Aujourd’hui, rencontrez Jinny Émond, préposée aux soins animaliers pour la plateforme de biologie in vivo.
![]()
-
31 octobre 2023 Une subvention de la SRC pour valider des cibles thérapeutiques dans le cancer du foie
L’équipe de Sylvain Meloche, directeur de l’Unité de recherche en signalisation et croissance cellulaire de l’IRIC, a obtenu une subvention de 125 000 $ pour deux ans pour le projet « Validation préclinique des tyrosine kinases de la famille SRC comme cibles thérapeutiques dans le cancer du foie ». Cet octroi est financé en partenariat avec la Fondation canadienne du foie.
![]()
-
31 octobre 2023 Lucyle Depoërs, doctorante et vulgarisatrice scientifique, présente le magazine l’ÉclairSci
L’IRIC est fier de soutenir la création du nouveau magazine l’ÉclairSci. Initié par la doctorante Lucyle Depoërs, du laboratoire de Claude Perreault, le projet présentera sous forme d’infographies vulgarisées des études scientifiques réalisées par des équipes de l’IRIC. Sous forme digitale, l’ÉclairSci se veut accessible à tous et toutes afin de partager les plus récentes avancées en cancérologie au grand public.
![]()
-
30 octobre 2023 Une nouvelle plateforme pour prédire la sécurité de composés médicamenteux
De par leur capacité d’activation de multiples voies de signalisation à différents endroits dans la cellule, les récepteurs couplés au protéines G (RCPG) sont des cibles de choix dans le développement de médicaments. Shane C. Wright, de l’Institut Karolinska en Suède, a réussi à exploiter une nouvelle technologie développée pendant son postdoctorat dans le laboratoire de Michel Bouvier, directeur général et directeur de l’Unité de recherche en pharmacologie moléculaire de l’IRIC, et qui pourrait être utilisée afin de prédire les effets indésirables de nouveaux traitements avant leur utilisation en clinique. L’étude, fruit de la collaboration des équipes suédoise et montréalaise, fait l’objet d’une publication dans le journal Nature Communications.
![]()
-
27 octobre 2023 Succès pour le symposium de l’IRIC 2023!
Les 19 et 20 octobre derniers, plus de 250 convives se sont réunis à l’occasion du symposium scientifique international de l’IRIC. L’événement était également l’occasion pour tous et toutes de souligner officiellement le 20e anniversaire de l’IRIC, à l’Université de Montréal.
![]()
-
27 septembre 2023 13 000$ amassés dans le cadre du Marathon Beneva de Montréal
Les 23 et 24 septembre derniers avait lieu le Marathon Beneva de Montréal et l’IRIC est fier d’avoir collecté plus de 13 000$ grâce aux généreux donateurs et donatrices.
![]()
-
26 septembre 2023 Célébration du 20e de l’IRIC et de sa communauté!
Le 18 septembre dernier, 300 personnes de la communauté étudiante et du personnel employé de l’IRIC se sont assemblées pour célébrer le 20e anniversaire de l’Institut.
![]()
-
20 septembre 2023 Annonce des récipiendaires du concours Science Réflexion 2023
L’IRIC a le plaisir de vous annoncer les noms des gagnants et gagnantes du concours Science Réflexion 2023. Ce concours annuel permet de mettre en lumière la créativité et le talent de la communauté de l’IRIC et de présenter la science sous un autre angle.
![]()
-
19 septembre 2023 Félicitations aux trois récipiendaires du Concours de Bourses salariales de l’IRIC
Trois membres de la communauté postdoctorale de l’IRIC ont remporté le Concours de bourses salariales de l’IRIC cette année. Ces bourses ont été remises grâce à l’engagement de donateurs fidèles.
![]()
-
7 septembre 2023 IRIC sur la route : une tournée de recrutement étudiant propulsée par l’équipe des affaires académiques
Dans le cadre de sa tournée de recrutement étudiant IRIC sur la route, l’équipe des affaires académiques de l’Institut participera cet automne à plusieurs salons d’études supérieures organisés par des universités canadiennes.
![]()
-
6 septembre 2023 Pasquale Gentile : un patient traité avec la molécule UM171 en visite à l’IRIC
Le 14 juillet dernier, Pasquale Gentile, un patient ayant reçu la thérapie d’expansion cellulaire basée sur la molécule UM171, était de passage dans les laboratoires de l’IRIC afin de visiter l’Unité de découverte de médicaments et de rencontrer Stéphane Gingras, le chimiste ayant synthétisé la molécule UM171
![]()
-
6 septembre 2023 KIF18A : une cible anticancer prometteuse pour des thérapies de combinaison avec des inhibiteurs de PLK1
La kinase PLK1 est impliquée à plusieurs niveaux dans le contrôle de la division cellulaire. Les cellules cancéreuses sont souvent particulièrement dépendantes de l’activité de cette enzyme. Les thérapies anticancer développées pour cibler PLK1 demeurent toutefois peu efficaces à ce jour. Le laboratoire du professeur Vincent Archambault, directeur de l’Unité de recherche sur la régulation du cycle cellulaire de l’IRIC, a collaboré avec le laboratoire du professeur Michael Tyers, alors directeur de l’Unité de recherche en biologie des systèmes et biologie synthétique, pour mieux comprendre les fonctions cellulaires de PLK1 et identifier des gènes dont l’inactivation interfère avec la prolifération cellulaire en synergie avec des inhibiteurs de PLK1 existants. Les résultats obtenus suggèrent que l’inhibition de la kinésine KIF18A pourrait s’avérer une avenue thérapeutique à exploiter en combinaison avec des inhibiteurs de PLK1. Publiée dans le journal PLOS Genetics, l’étude a été menée par la conseillère à la recherche Karine Normandin.
![]()
-
24 août 2023 Capitaine Mathilde : conjuguer course et science au profit de la recherche
Conseillère à la recherche dans le laboratoire de Sylvain Meloche, qui dirige l’Unité de recherche en signalisation et croissance cellulaire, Mathilde Soulez a accepté pour une troisième année consécutive d’enfiler le dossard de capitaine de l’Équipe IRIC dans le cadre du Marathon Beneva de Montréal. Scientifique, coureuse, entraîneuse, maman; entretien avec une femme aux talents et intérêts multiples.
![]()
-
24 août 2023 Les piliers de l’IRIC : rencontrez Madeleine Héroux
En 2023, l’IRIC fête ses 20 ans. Parmi les initiatives mises en place pour célébrer cet anniversaire, la série de portraits « Les piliers de l’IRIC » permettra de mettre en lumière les personnes qui ont contribué depuis les tous débuts, parfois dans l’ombre, à faire de l’IRIC ce qu’il est devenu.
Aujourd’hui, faites la rencontre de Madeleine Héroux, directrice adjointe – biologie de l’Unité de découverte du médicament.
![]()
-
18 août 2023 La Journée des stagiaires d’été de l’IRIC 2023 : L’occasion de s’initier à la communication scientifique
La cinquième édition de la Journée des stagiaires d’été de l’IRIC s’est tenue le jeudi 10 août dernier. L’événement, organisé par le Bureau des affaires académiques de l’IRIC de pair avec des stagiaires d’été a permis à 11 stagiaires de s’initier à la communication scientifique devant leurs pairs et leurs collègues de l’IRIC. Un total de quatre présentations orales et de sept présentations par affiches a été mis en œuvre.
![]()
-
2 août 2023 Les piliers de l’IRIC : rencontrez Simon Girard
En 2023, l’IRIC fête ses 20 ans. Parmi les initiatives mises en place pour célébrer cet anniversaire, la série de portraits « Les piliers de l’IRIC » permettra de mettre en lumière les personnes qui ont contribué depuis les tous débuts, parfois dans l’ombre, à faire de l’IRIC ce qu’il est devenu.
Aujourd’hui, rencontrez Simon Girard, conseiller à la recherche dans le laboratoire de Guy Sauvageau à l’IRIC.
![]()
-
1er août 2023 Identification de la protéine Emerin comme cible de la phosphatase PP2A-B55 : une régulation clé pour la sortie de mitose
L’Unité de recherche sur la régulation du cycle cellulaire et l’Unité de recherche en protéomique et spectrométrie de masse de l’IRIC, dirigées respectivement par les professeurs Vincent Archambault et Pierre Thibault, ont tiré avantage de la mouche à fruits Drosophila melanogaster pour identifier des protéines cibles de PP2A-B55. Leurs résultats révèlent que la protéine de l’enveloppe nucléaire Emerin est déphosphorylée par PP2A-B55; une régulation importante pour la reformation de l’enveloppe nucléaire et le développement embryonnaire. Menée conjointement par les doctorantes Virginie Emond-Fraser et Myreille Larouche, l’étude fait l’objet d’une publication dans le journal Open Biology de la Royal Society.
![]()
-
24 juillet 2023 Quatre équipes de l’IRIC obtiennent du financement des Instituts de recherche en santé du Canada
Les Instituts de recherche en santé du Canada (IRSC) ont récemment attribué les subventions du programme Projet pour le concours du printemps 2023. Ce programme vise à soutenir les idées originales ayant le potentiel de faire avancer les connaissances fondamentales et appliquées en santé. Au pays, ce sont 381 projets de recherche, représentant un investissement total de 325 millions de dollars, qui ont été financés. Quatre projets de l’IRIC sont récipiendaires de ces prestigieux octrois.
![]()
-
19 juillet 2023 École d’été de l’UdeM : une opportunité pour la relève de s’initier à la biologie moléculaire dans nos laboratoires
Dans le cadre de l’École d’été de l’Université de Montréal, 8 jeunes de 15 à 17 ans ont pu participer le 4 juillet dernier à un atelier thématique dans les laboratoires de l’IRIC. Animé par les étudiantes au doctorat Fadia Boudghene-Stambouli, Eloïse Duramé et Chloé Tesnière, l’atelier d’une demi-journée leur a permis d’expérimenter pour apprendre sur la biologie moléculaire et la cancérologie.
![]()
-
6 juillet 2023 Identification d’une nouvelle voie pro-motilité impliquant la protéine CNK2 dans les cellules cancéreuses
À l’IRIC, Marc Therrien et son équipe cherchent à comprendre comment la transduction des signaux est perturbée dans les cellules cancéreuses, leur permettant de se diviser et de se propager dans l’organisme même en l’absence des signaux appropriés. Le projet dirigé par les doctorants Jessica Gagnon et Guillaume Serwe, et l’associé de recherche David Kachaner, a été publié dans le journal Nature Communications et décrit une nouvelle voie de signalisation dans laquelle la protéine d’échafaudage CNK2 joue un rôle central pour l’augmentation de la motilité des cellules cancéreuses. Les équipes de recherche de Gregory Emery et Sylvain Meloche à l’IRIC ont également contribué à cette étude.
![]()
-
5 juillet 2023 Visitez la nouvelle boutique IRIC !
L’IRIC est fier de lancer sa nouvelle boutique en ligne. Que ce soit pour un événement sportif ou simplement au quotidien, faites rayonner l’Institut en portant ses couleurs.
![]()
-
5 juillet 2023 La Société de leucémie et lymphome du Canada remet deux prix nommés en l’honneur de membres de l’IRIC
La Société de leucémie et lymphome du Canada (SLLC) remet chaque année six prix mettant en lumière les contributions des bénévoles et du personnel de l’organisation. Deux de ces prix ont été nommés en l’honneur de membres de l’IRIC : le Prix Dre Trang Hoang – Professionnel(le) de la santé de l’année et le Prix William Brock – Courage et inspiration. L’IRIC est très fier de pouvoir compter au quotidien sur ces deux modèles d’engagement.
![]()
-
4 juillet 2023 ENPP1 réduit la réponse immunitaire dans les cancers du sein HER2+
HER2∆16 est un variant oncogénique du récepteur du facteur de croissance épidermique humain (HER2); il est impliqué dans les cancers du sein et d’autres types de tumeurs comme moteur de la tumorigenèse et du processus métastatique. Le laboratoire du professeur Philippe Roux, directeur de l’Unité de recherche en signalisation cellulaire et protéomique de l’IRIC, a collaboré avec l’équipe de William Muller, de l’Institut de cancer Rosalind et Morris Goodman de l’Université McGill, pour caractériser les mécanismes moléculaires sous-jacents de l’oncogénicité médiée par HER2Δ16. Les résultats obtenus suggèrent que HER2Δ16 altère le microenvironnement tumoral via la protéine ENPP1, qui pourrait s’avérer être une cible thérapeutique intéressante. Publiée dans le journal Cancer Immunology Research, l’étude a été menée conjointement par Jonathan Boucher, postdoctorant dans le laboratoire de Philippe Roux, et Sherif Samer Attalla, étudiant au doctorat dans le laboratoire Muller.
![]()
-
28 juin 2023 Concours de recrutement étudiant 2023 : une édition sous le signe des rencontres
L’édition 2023 s’est déroulée du 7 au 9 juin et a accueilli 23 participants et participantes provenant de 19 universités à travers le monde. Plus de cent entrevues ont été planifiées cette année entre les participants et participantes et les 12 chercheuses et chercheurs de l’Institut présents à l’événement.
![]()
-
28 juin 2023 Les piliers de l’IRIC : rencontrez Isabelle Caron
En 2023, l’IRIC fête ses 20 ans. Parmi les initiatives mises en place pour célébrer cet anniversaire, la série de portraits « Les piliers de l’IRIC » permettra de mettre en lumière les personnes qui ont contribué depuis les tous débuts, parfois dans l’ombre, à faire de l’IRIC ce qu’il est devenu.
Aujourd’hui, rencontrez Isabelle Caron, technicienne en santé animale pour la plateforme de Biologie in vivo.
![]()
-
15 juin 2023 Un Prix du recteur remis à Julie Mantovani pour le projet des Pauses connexion
Les Prix du recteur 2023 de l’Université de Montréal ont été remis le 12 juin pour célébrer les réalisations et l’engagement de membres du personnel qui se démarquent et illustrent de manière exceptionnelle les valeurs universitaires. L’IRIC félicite Julie Mantovani, cheffe des affaires académiques, qui a reçu le prix Innovation lors de la cérémonie. Ce prix célèbre une personne qui ose le changement en proposant et en mettant en œuvre de nouvelles idées.
![]()
-
13 juin 2023 Les piliers de l’IRIC : rencontrez Raphaëlle Lambert
En 2023, l’IRIC fête ses 20 ans. Parmi les initiatives mises en place pour célébrer cet anniversaire, la série de portraits « Les piliers de l’IRIC » permettra de mettre en lumière les personnes qui ont contribué depuis les tous débuts, parfois dans l’ombre, à faire de l’IRIC ce qu’il est devenu.
Aujourd’hui, rencontrez Raphaëlle Lambert, responsable de la plateforme de génomique de l’IRIC.
![]()
-
2 juin 2023 Les récipiendaires des bourses IRIC scientifiques de demain 2023 arrivent à l’Institut
Ce concours de bourses permet à des étudiants et étudiantes de premier cycle de venir effectuer un stage de recherche de 12 à 16 semaines à l’IRIC pendant le trimestre d’été.
![]()
-
2 juin 2023 Un prix du public pour Juliette Humeau lors de la finale provinciale de Science POP
La finale provinciale du concours de communication scientifique Science POP s’est tenue les 27 et 28 mai derniers. Dans la catégorie vulgarisation, Juliette Humeau, postdoctorante dans le laboratoire de Claude Perreault, a remporté le prix du public pour sa présentation « L’action coordonnée des cellules immunitaires dans la lutte anticancéreuse ».
![]()
-
31 mai 2023 Nomination de Philippe Roux au poste de directeur scientifique de l’IRIC
L’IRIC est heureux d’annoncer la nomination du professeur Philippe Roux au poste de directeur scientifique de l’Institut pour un mandat de deux ans. Le Conseil de l’Université de Montréal a récemment entériné la recommandation du conseil d’administration de l’IRIC. Le professeur Roux devient ainsi le troisième directeur scientifique de l’histoire de l’Institut, qui souligne ses 20 ans d’existence en 2023. Il succède à ce poste au professeur Marc Therrien, qui assumait cette fonction avec brio depuis 2013.
![]()
-
31 mai 2023 La relève à l’honneur lors de la Journée scientifique de l’IRIC 2023
La 10e Journée scientifique de l’IRIC, tenue le 26 mai dernier, a permis de mettre en lumière le travail de la communauté scientifique de l’Institut. Plus de 150 personnes ont participé à l’événement qui comptait 12 présentations orales et 63 présentations par affiche au programme. Celles-ci ont suscité discussions et échanges dynamiques, qui pourront nourrir les réflexions de tous et toutes
![]()
-
30 mai 2023 Les piliers de l’IRIC : rencontrez Caroline Baril
En 2023, l’IRIC fête ses 20 ans. Parmi les initiatives mises en place pour célébrer cet anniversaire, la série de portraits « Les piliers de l’IRIC » permettra de mettre en lumière les personnes qui ont contribué depuis les tous débuts, parfois dans l’ombre, à faire de l’IRIC ce qu’il est devenu.
Aujourd’hui, rencontrez Caroline Baril, agente de recherche dans le laboratoire de Marc Therrien à l’IRIC.
![]()
-
26 mai 2023 Fondation de Richard et Edith Strauss : un soutien renouvelé de 300 000$!
Depuis 2019, grâce au généreux soutien de la Fondation de Richard et Edith Strauss, les chercheurs, les chercheuses et leurs équipes peuvent approfondir les recherches sur la leucémie pédiatrique et la leucémie aiguë myéloïde (LMA) et ainsi repousser les limites de la science sur ces types de cancer.
![]()
-
26 mai 2023 Renouvellement du mandat de Michel Bouvier au poste de directeur général de l’IRIC
À l’issue de la 0178e séance tenue le 11 avril 2023, le Comité exécutif de l’Université de Montréal a nommé Michel Bouvier à titre de directeur général exécutif de l’Institut de recherche en immunologie et en cancérologie (IRIC) et ce, pour un quatrième mandat qui débutera le 1er juin 2023 et se terminera le 31 mai 2024.
![]()
-
25 mai 2023 Une subvention NOVA pour Delphine Bouilly et ses partenaires
L’IRIC félicite Delphine Bouilly, directrice de l’Unité de recherche en conception et application de nanobiocapteurs électroniques, qui a obtenu une subvention NOVA de 225 000 $ sur trois ans pour le projet « Dispositifs de graphène bicouche fonctionnalisés : atteindre sélectivité et sensibilité ». Offerte conjointement par les Fonds de recherche du Québec – Nature et technologies et le Conseil de recherches en sciences naturelles et en génie du Canada, cette subvention soutient des projets de recherche dirigés par des chercheurs ou chercheuses de la relève du Québec en collaboration avec des chercheurs ou chercheuses des autres provinces canadiennes et territoires.
![]()
-
17 mai 2023 La chercheuse Geneviève Deblois obtient un Prix Forbeck !
Geneviève Deblois, directrice de l’Unité de recherche sur les mécanismes épigénétiques et métabolisme du cancer de l’IRIC, fait partie des 13 récipiendaires du Prix Forbeck 2022-2023. « Ce prix me permettra de faire partie d’un groupe de chercheuses et chercheurs spécialisés, dont plusieurs reconnus mondialement dans des domaines de recherches connexes au mien. », explique Geneviève Deblois.
![]()
-
17 mai 2023 Identification de Supervilline comme cible de ERK3 : des implications pour la complétion de la cytocinèse
Malgré des rôles potentiels dans la tumorigenèse des cellules de cancer du poumon et du sein, la protéine kinase atypique ERK3, membre de la voie Ras/MAPK, n’est que très peu caractérisée. Le laboratoire du professeur Sylvain Meloche, directeur de l’Unité de recherche en signalisation et croissance cellulaire, a collaboré avec le laboratoire du professeur Jean-Claude Labbé, directeur de l’Unité de recherche en division et différenciation cellulaire, tous deux à l’IRIC, pour identifier les cibles de ERK3 et mieux comprendre ses fonctions cellulaires. Les travaux menés ont permis d’identifier la protéine Supervilline comme étant une cible de ERK3. Publiée dans le Journal of Cellular Physiology, l’étude a été menée conjointement par le postdoctorant Joaquim Javary et la conseillère à la recherche Eugénie Goupil, avec la collaboration de la conseillère à la recherche Mathilde Soulez.
![]()
-
5 mai 2023 Treize membres de l’IRIC sont récipiendaires de bourses et subventions des Fonds de recherche du Québec pour l’année 2023-2024
Les Fonds de recherche du Québec (FRQ) offrent 58,6 M$ en bourses de formation, 13,1 M$ en bourses de carrière et 29,8 M$ en subventions de recherche pour un total de 101,5 M$ en nouveaux octrois pour l’année 2023-2024. L’IRIC est fier de compter plusieurs de ses membres parmi les lauréats et lauréates de ces concours.
![]()
-
5 mai 2023 Trois finalistes représenteront l’IRIC lors de la finale provinciale de Science Pop
Tenue le 12 avril dernier, la compétition interne de l’IRIC a couronné trois finalistes qui prendront part à la finale provinciale du concours panquébécois de communication scientifique Science Pop, les 27 et 28 mai prochains.
![]()
-
4 mai 2023 Les piliers de l’IRIC: rencontrez Éric Bonneil
En 2023, l’IRIC fête ses 20 ans. Parmi les initiatives mises en place pour célébrer cet anniversaire, la série de portraits « Les piliers de l’IRIC » permettra de mettre en lumière les personnes qui ont contribué depuis les tous débuts, parfois dans l’ombre, à faire de l’IRIC ce qu’il est devenu.
Aujourd’hui, rencontrez Éric Bonneil, responsable de la plateforme de protéomique de l’IRIC.
![]()
-
4 mai 2023 Soirée-bénéfice de l’IRIC : 505 000 $ amassés pour Audace 2023
Le 27 avril dernier, plus de 250 convives se sont réunis à l’occasion du 20e anniversaire de l’IRIC lors de son événement-bénéfice Audace. Grâce à la générosité des invités et des donateurs, plus de 505 000 $ ont été amassés afin de pérenniser la mission de l’IRIC et améliorer les thérapies contre le cancer.
![]()
-
4 mai 2023 L’Université de Montpellier décerne un doctorat honorifique à Michel Bouvier
Un doctorat honoris causa a été remis à Michel Bouvier pour ses travaux sur les récepteurs couplés aux protéines G (RCPG) et sa contribution aux avancées scientifiques dans le domaine de la pharmacologie moléculaire. La plus haute distinction de l’enseignement supérieur lui a été décernée par l’Université de Montpellier au cours d’une cérémonie qui s’est tenue le 13 avril dernier.
![]()
-
2 mai 2023 Félicitations aux récipiendaires des Bourses de congrès de l’IRIC - Compétition Hiver 2023
L’objectif du concours est de favoriser la participation des étudiants à la maîtrise, au doctorat et des stagiaires postdoctoraux de l’IRIC à des congrès scientifiques de grande envergure qui se déroulent hors de la province du Québec.
![]()
-
4 avril 2023 Découverte de nouveaux rôles pour eIF4E : reprogrammation de masse de l’épissage pour changer le message
L’équipe de la professeure Katherine Borden, directrice de l’Unité en structure et fonction du noyau cellulaire de l’IRIC, a voulu comprendre comment l’épissage alternatif était détourné chez certaines personnes atteintes de la leucémie myéloïde aiguë (LMA) qui ne présentent pas les mutations de l’ADN habituellement impliquées dans ce détournement. L’étude de modèles de laboratoires et d’échantillons de personnes leucémiques a permis de découvrir que l’épissage de milliers d’ARNs pouvait être altéré de façon insoupçonnée par la protéine oncogène eIF4E, conférant des propriétés cancéreuses aux cellules. Publié dans le journal EMBO, le travail a été mené conjointement par les postdoctorants Mehdi Ghram et Gavin Morris, ainsi que par l’associée de recherche Biljana Culjkovic-Kraljacic.
![]()
-
14 mars 2023 Plus de 10 000$ amassés pour la première édition de FOCUS!
Du 9 février au 12 février 2023 avait lieu la première édition de FOCUS, une exposition présentant la science sous un angle artistique grâce au talent créatif de la communauté scientifique de l’IRIC. L’exposition a mis en lumière des œuvres scientifiques créées par la communauté de l’Institut à Projet Casa, une salle d’exposition montréalaise fondée par des mécènes de longue date de l’IRIC : Danielle Lysaught et Paul Hamelin.
![Focus]()
-
14 mars 2023 Les piliers de l’IRIC: rencontrez Nadine Mayotte
En 2023, l’IRIC fête ses 20 ans. Parmi les initiatives mises en place pour célébrer cet anniversaire, la série de portraits « Les piliers de l’IRIC » permettra de mettre en lumière les personnes qui ont contribué depuis les tous débuts, parfois dans l’ombre, à faire de l’IRIC ce qu’il est devenu.
Aujourd’hui, rencontrez Nadine Mayotte, conseillère à la recherche dans le laboratoire de Guy Sauvageau à l’IRIC.
![]()
-
14 mars 2023 Le chercheur Gregory Emery obtient une subvention des Instituts de recherche en santé du Canada
Le concours de subventions Projet des Instituts de recherche en santé du Canada (IRSC) vise à soutenir les idées originales ayant le potentiel de faire avancer les connaissances fondamentales et appliquées en santé. La plus récente édition du concours, tenue à l’automne 2022, a financé 382 demandes, pour un investissement total de 325 millions de dollars. L’IRIC tient à féliciter Gregory Emery, directeur de son Unité de recherche en transport vésiculaire et signalisation cellulaire, qui est du nombre. Une subvention de 963 900 $ sur cinq ans lui a été octroyée pour le projet « Régulation de la migration cellulaire collective par la kinase Misshapen ».
![]()
-
8 mars 2023 Le chercheur David Knapp obtient une subvention de l’Institut de recherche Terry Fox
David Knapp, directeur de l’Unité de recherche en ingénierie cellulaire de l’IRIC, fait partie des récipiendaires 2023 des Terry Fox New Investigator Awards. Il recevra 433 850 $ sur trois ans pour le projet « Compréhension des mécanismes moléculaires de l’hématopoïèse clonale associée à l’âge ».
![]()
-
8 mars 2023 Signature d’un accord de licence exclusif et d’une nouvelle collaboration de recherche en oncologie avec la compagnie Ipsen
L’Institut de recherche en immunologie et en cancérologie de l’Université de Montréal, l’IRIC, est fier d’annoncer que la compagnie Ipsen a exercé son option de licence pour l’acquisition des droits exclusifs d’un de ses programmes de recherche pré-clinique en oncologie, résultat d’une collaboration de recherche fructueuse entre Ipsen, IRICoR, et l’Université de Montréal, initiée en mai 2020. Ipsen mènera désormais l’ensemble des activités de développement et de commercialisation de ce candidat-médicament à l’échelle mondiale.
![]()
-
7 mars 2023 Bourses de maîtrise et de doctorat de l’IRIC – Récipiendaires du Concours Automne 2022
L’objectif du Concours Bourses de maîtrise et de doctorat de l’IRIC 2022-2023 est d’appuyer les étudiantes et étudiants de l’IRIC qui ont un excellent dossier académique et de recherche, mais qui ne bénéficient pas de bourse nominale majeure. Les bourses de maîtrise et doctorat sont offertes grâce à l’appui de la grande communauté de l’IRIC : ses employées et employés, ses chercheuses et chercheurs et ses généreuses et généreux donateurs et partenaires. L’octroi de ces bourses est également rendu possible grâce à l’implication de plusieurs bénévoles.
![]()
-
16 février 2023 L’IRIC adopte de nouvelles lignes directrices pour les versements des bourses de maîtrise et de doctorat
Dans le contexte inflationniste actuel, l’IRIC a adopté en janvier 2023 de nouvelles mesures pour améliorer les conditions de vie et de travail de sa communauté étudiante. Le coût de la vie ayant augmenté en deux décennies, et particulièrement au cours des deux dernières années, les nouvelles lignes directrices adoptées par l’IRIC permettront de réduire le stress financier de sa communauté étudiante et de fournir un climat plus sain pour réaliser des études.
![]()
-
13 février 2023 Les piliers de l’IRIC: rencontrez Gabrielle Jacob
En 2023, l’IRIC fête ses 20 ans. Parmi les initiatives mises en place pour célébrer cet anniversaire, la série de portraits « Les piliers de l’IRIC » permettra de mettre en lumière les personnes qui ont contribué depuis les tous débuts, parfois dans l’ombre, à faire de l’IRIC ce qu’il est devenu. Aujourd’hui, rencontrez Gabrielle Jacob, technicienne en administration au sein de l’équipe des finances de l’IRIC.
![]()
-
6 février 2023 Un soutien renouvelé au Fonds Valérie Blais
Un soutien renouvelé au Fonds Valérie Blais
![]()
-
2 février 2023 L’IRIC et ses partenaires se rencontrent à Montpellier pour développer un programme de maîtrise internationale
Fruit d’une collaboration entre l’IRIC, l’Université de Montréal, l’Université de Montpellier en France et l’Université de Pavie en Italie, le projet « MAD4Cancer – Towards an International Master Degree in Cancer Biology » a obtenu un financement Erasmus Mondus Design Measures de 55 000 euros pour 15 mois. L’objectif du projet est de mettre sur pied un programme de maîtrise international en biologie du cancer permettant aux étudiantes et étudiants de fréquenter les trois universités partenaires.
![]()
-
27 janvier 2023 La Fondation Jean Gaulin fait un don de 24 420$ au Fonds général de l’IRIC
La fondation familiale privée de Jean Gaulin a comme mission de soutenir le bien-être de la communauté. Depuis plusieurs années, la fondation appuie l’Institut et veille à approfondir les connaissances en immunologie et en cancérologie. Ce don contribua à convertir les découvertes des chercheurs et chercheuses en solutions thérapeutiques novatrices pour le bien-être des personnes touchées par le cancer.
![]()
-
20 janvier 2023 Nomination de William Brock à titre de président du conseil d’administration de l’IRIC
L’IRIC annonce avec enthousiasme la nomination de Me William Brock, avocat émérite du Barreau du Québec, à titre de nouveau président du CA.
![]()
-
7 décembre 2022 L’utilisation du marqueur CAXII pourrait améliorer la classification des tumeurs mammaires
Le cancer du sein est une maladie hétérogène, qui ne peut être ciblée efficacement par un traitement commun et unique. Dans deux tiers des cas, le récepteur des œstrogènes de type alpha (ERα), un récepteur activé par les hormones sexuelles, est exprimé et peut être ciblé thérapeutiquement par une hormonothérapie. Toutefois, les niveaux d’ERα peuvent varier d’une tumeur à l’autre et à l’intérieur même des tumeurs, compliquant sa détection et le choix subséquent de la thérapie. Le récepteur de la progestérone (PR) est couramment utilisé en clinique comme co-marqueur de sélection de tumeurs se qualifiant pour une hormonothérapie. En effet, ce marqueur régulé par les œstrogènes est censé refléter l’activité d’ERa. Dans une nouvelle étude parue dans le journal Cancers, Sylvie Mader, directrice de l’Unité de recherche en ciblage moléculaire dans le traitement du cancer du sein de l’IRIC, et son étudiant au doctorat Lucas Porras montrent que la détection de PR reflète imparfaitement l’activité d’ERα et identifient un nouveau co-marqueur plus fiable.
![]()
-
28 novembre 2022 Une greffe de moelle osseuse unit Dr Claude Perreault et Dr Robert Patenaude depuis maintenant 40 ans
Novembre 2022 marque le 40e anniversaire d’une rencontre clé ayant permis à Robert Patenaude de devenir l’un des premiers bénéficiaires d’une greffe de moelle osseuse au pays. Retour sur cette histoire unissant solidement Robert Patenaude à Claude Perreault depuis maintenant quatre décennies.
![]()
-
24 novembre 2022 Identification de CDK12 comme nouvelle cible de la voie RAS/MAPK : des implications pour le traitement des mélanomes
Le laboratoire du professeur Philippe P. Roux, directeur de l’Unité de recherche en signalisation cellulaire et protéomique, s’est intéressé aux mécanismes associés à cette résistance. Pour découvrir des cibles anti-cancéreuses plus efficaces, l’équipe a cherché à identifier les effecteurs clés de la voie RAS/MAPK, une voie de signalisation suractivée dans les mélanomes. Les travaux effectués ont permis d’identifier la protéine CDK12 comme étant une cible directe de la voie et de mettre en lumière son rôle important dans les cellules de mélanome. Le projet a été mené par le postdoctorant Thibault Houles et fait l’objet d’une publication dans le journal Nature Communications.
![]()
-
21 novembre 2022 Brian Wilhelm et ses partenaires reçoivent plus de 2 millions de dollars pour un projet de recherche sur les leucémies pédiatriques
Un partenariat inédit rassemblant le Conseil québécois sur la découverte du médicament (CQDM), la Société canadienne du cancer (SCC), la Fondation Cole, l’Oncopole, des philanthropes et des entreprises québécoises a permis de remettre 8 485 132 $ à quatre équipes montréalaises pour leurs projets de recherche sur les cancers pédiatriques. Parmi ces dernières se trouve l’équipe de Brian Wilhelm, directeur de l’Unité de recherche en génomique à haut débit à l’IRIC et professeur agrégé au Département de médecine de la Faculté de médecine de l’Université de Montréal.
![]()
-
25 octobre 2022 Objectifs atteints pour les événements sportifs au bénéfice de l’IRIC
Cet automne, notre communauté a eu l’occasion de se joindre à trois initiatives sportives de renom en participant à différentes compétitions et / ou en soutenant la cause de l’IRIC. Au total, une somme de 21 325 $ a pu être remise à l’Institut grâce à la générosité et à la détermination de nos amatrices et amateurs de sports! Retour sur ces événements.
![]()
-
24 octobre 2022 Un jeune chercheur qui a le vent dans les voiles
David Knapp, directeur de l’Unité de recherche en ingénierie cellulaire de l’IRIC et professeur adjoint au Département de pathologie et biologie cellulaire de la Faculté de médecine de l’Université de Montréal, cumule les bons coups, deux ans seulement après l’établissement de son groupe de recherche. Faisant partie des plus récents récipiendaires du concours annuel de subventions de la Société de recherche sur le cancer, David Knapp et son équipe ont également collaboré à deux études publiées cet été. Retour sur ces accomplissements.
![]()
-
21 octobre 2022 La postdoctorante Juliette Humeau obtient une bourse salariale
Dans le cadre de son plus récent Concours de bourses salariales de l’IRIC, tenu cet automne, l’IRIC a remis une bourse postdoctorale grâce au fonds Power Corporation Canada de la relève scientifique. Juliette Humeau, postdoctorante dans le laboratoire de Claude Perreault, s’est vue octroyée ce financement en raison de la qualité de son dossier académique et scientifique.
![]()
-
13 octobre 2022 Les Grandes Retrouvailles à l’IRIC : quand les portes des laboratoires s’ouvrent pour le grand public
L’Université de Montréal a tenu ses premières Grandes Retrouvailles sur ses différents campus, du 28 septembre au 2 octobre derniers. Dans le cadre de l’événement, qui comptait une cinquantaine d’activités, 17 personnes ont pu visiter les installations de l’IRIC et découvrir son modèle de recherche en cancérologie.
![]()
-
11 octobre 2022 Une percée majeure née d’une collaboration internationale ouvre le chemin vers le soulagement de la douleur
Le projet est le fruit d’une collaboration internationale entre des groupes de recherche de différents domaines : Brian Shoichet et Allan Basbaum, tous deux chercheurs à l’University of California San Francisco, Peter Gmeiner de l’Université Freidrichs Alexander en Allemagne, Yang Du de l’Université chinoise de Hong Kong et Michel Bouvier, directeur général de l’IRIC et directeur de l’Unité de recherche en pharmacologie moléculaire. Ces travaux font l’objet d’une publication dans le journal Science.
![]()
-
3 octobre 2022 Deux projets de l’IRIC retenus lors du plus récent concours annuel de la Société de recherche sur le cancer
La Société de recherche sur le cancer (SRC) a dévoilé les récipiendaires des 90 nouvelles subventions de recherche octroyées lors de son plus récent concours annuel. Deux équipes de l’IRIC en font partie.
![]()
-
23 septembre 2022 Deux nouveaux récipiendaires se méritent une Bourse postdoctorale Power Corporation du Canada de la relève scientifique
À l’issue du concours de Bourses postdoctorales Power Corporation du Canada de la relève scientifique, tenu cet été, deux postdoctorants de l’IRIC se méritent un financement grâce à la qualité de leurs travaux de recherche.
![]()
-
16 septembre 2022 Quatre étudiantes et étudiants de l’IRIC obtiennent du financement pour aller présenter leurs résultats de recherche hors Québec
Dans le cadre de son plus récent concours de Bourses de congrès, l’IRIC a remis des bourses à quatre doctorantes et doctorants. Ce soutien financier leur permettra de présenter leurs résultats de recherche lors de congrès scientifiques tenus en dehors du Québec.
![]()
-
12 septembre 2022 L’engagement exceptionnel de la Katelyn Bedard Bone Marrow Association
L’IRIC désire mettre en lumière le soutien exemplaire de la Katelyn Bedard Bone Marrow Association qui appuie depuis 15 ans les travaux de l’équipe du Dr Claude Perreault. En 2022, un don de 10 000 $ a été acheminé et à ce jour, c’est un montant de 90 000 $ qui a été versé au laboratoire Perreault pour propulser la recherche sur la transplantation de cellules hématopoïétiques et le traitement des leucémies.
![]()
-
9 septembre 2022 IRIC sur la route : l’équipe des affaires académiques entreprend une tournée de recrutement
Dans le cadre de sa tournée de recrutement étudiant IRIC sur la route, l’équipe des affaires académiques de l’Institut participera cet automne à plusieurs salons d’études supérieures organisés par des universités canadiennes.
![]()
-
7 septembre 2022 Katherine Borden est élue à la Société royale du Canada
La professeur Katherine Borden, directrice de l’Unité de recherche en structure et fonction du noyau cellulaire de l’IRIC et professeure titulaire au Département de pathologie et biologie cellulaire de la Faculté de médecine de l’Université de Montréal, a été élue membre de l’Académie des sciences de la Société royale du Canada (SRC).
![]()
-
22 août 2022 Une molécule chimique conçue à l’IRIC a été nommée « molécule du mois » en juin 2022 par la plateforme Drug Hunter
Candidat clinique conçu et synthétisé à l’IRIC par l’Unité de Découverte du Médicament dirigée par la chercheuse principale Anne Marinier, la molécule BMS-986120 (UDM-002985) a été nommée « molécule du mois » par la plateforme Drug Hunter.
![]()
-
11 août 2022 La Journée des stagiaires d’été de l’IRIC : une belle expérience pour apprendre à communiquer ses résultats de recherche
La quatrième édition de la Journée des stagiaires d’été de l’IRIC s’est tenue le jeudi 11 août 2022. L’événement, organisé par le Bureau des affaires académiques de l’IRIC de pair avec les stagiaires d’été, a permis à 10 stagiaires de s’initier à la communication scientifique.
![]()
-
21 juillet 2022 Découverte d’une nouvelle avenue thérapeutique ciblant le cycle cellulaire dans un sous-type de leucémie myéloïde aiguë
Le projet, mené par l’agente de recherche Céline Moison, fait l’objet d’une publication dans le journal Blood Advances. Le travail a été réalisé grâce à la collaboration des équipes de Guy Sauvageau et Anne Marinier à l’IRIC, Josée Hébert de l’Hôpital Maisonneuve-Rosemont et Vincent-Philippe Lavallée du CHU Sainte-Justine.
![]()
-
19 juillet 2022 Quatre chercheurs de l’IRIC obtiennent du financement des Instituts de recherche en santé du Canada
À l’issue du plus récent concours de subventions de recherche des Instituts de recherche en santé du Canada (IRSC), quatre chercheurs de l’IRIC obtiennent des fonds du programme de subvention Projet.
![]()
-
8 juillet 2022 Cinq finissantes et finissants de l’IRIC nominés à la liste d’honneur du Recteur de l’Université de Montréal
L’IRIC est fier de compter cinq de ses finissants et finissantes parmi les plus récentes nominations à la liste d’honneur du Recteur.
![]()
-
5 juillet 2022 Trois chercheurs de l’IRIC reçoivent des fonds du Conseil des recherches en sciences naturelles et en génie du Canada
Le Conseil des recherches en sciences naturelles et en génie du Canada (CRSNG) a récemment dévoilé les résultats de son concours de subvention de recherche 2022. Plus de 430 millions de dollars seront remis à des chercheurs et chercheuses de partout au pays afin de mener à bien leurs programmes de recherche. À l’issue du concours 2022, trois chercheurs de l’IRIC se sont vus octroyer des subventions.
![]()
-
29 juin 2022 L’IRIC recrute le Dr Vincent Q. Trinh à titre de chercheur principal
L’Institut de recherche en immunologie et en cancérologie (IRIC) de l’Université de Montréal est fier de souligner l’arrivée en ses murs d’un nouveau chercheur principal à l’Unité de recherche en histologie digitale et pathologie avancée, le Dr Vincent Q. Trinh, lequel entrera en fonction le 1er juillet 2022.
![]()
-
29 juin 2022 Rencontrez Vincent Q. Trinh, nouveau chercheur à l’IRIC
L’Institut de recherche en immunologie et en cancérologie (IRIC) de l’Université de Montréal est fier de souligner l’arrivée en ses murs d’un nouveau chercheur principal à l’Unité de recherche en histologie digitale et pathologie avancée, le Dr Vincent Q. Trinh, lequel entrera en fonction le 1er juillet 2022. Dr Trinh a accepté avec enthousiasme de répondre à quelques questions.
![]()
-
27 juin 2022 Hyperactivation de la voie NOTCH1 dans la leucémie aiguë lymphoblastique à cellules T : deux publications récentes apportent un nouvel éclairage
L’équipe de Trang Hoang, directrice de l’unité de recherche en hématopoïèse et leucémie de l’IRIC, s’est intéressée à l’hyperactivation de NOTCH1 dans la T-ALL. Le travail de Diogo Veiga, postdoctorant désormais professeur de génomique et bio-informatique à l’Universidade Estadual de Campinas au Brésil, et Mathieu Tremblay, conseiller à la recherche, a permis la publication de deux articles.
![]()
-
22 juin 2022 Michel Bouvier nommé Chevalier de l’Ordre national du Québec
Le 22 juin 2022, Michel Bouvier, directeur général de l’IRIC, chercheur principal de l’Unité de recherche en pharmacologie moléculaire et Professeur au Département de biochimie et médecine moléculaire de la Faculté de médecine de l’Université de Montréal est nommé Chevalier de l’Ordre national du Québec.
![]()
-
21 juin 2022 Bourses IRIC scientifiques de demain 2022: douze stagiaires travailleront à l’IRIC cet été
Douze étudiantes et étudiants ont l’opportunité de compléter un stage de recherche de 12 ou de 16 semaines à l’IRIC, en plus de bénéficier d’une bourse d’excellence d’un montant de 4 800$ ou de 6400$ respectivement.
![]()
-
21 juin 2022 Retour en présentiel pour l’édition 2022 du Concours de recrutement étudiant de l’IRIC
L’édition 2022 du concours s’est déroulée du 1 au 3 juin et a accueilli 29 participants et participantes provenant de 18 universités à travers le monde. Cent-cinquante-trois entrevues ont été planifiées cette année entre les participants et participantes et les 14 chercheuses et chercheurs de l’Institut présents à l’événement.
![]()
-
8 juin 2022 Neuf scientifiques de la relève de l’IRIC reçoivent une bourse de formation des Fonds de recherche du Québec
À l’issue des concours 2022-2023, les Fonds de recherche du Québec (FRQ) ont remis 39,3M$ en bourses de formation. L’IRIC est fier de compter neuf scientifiques de sa relève parmi les lauréats et lauréates des concours.
![]()
-
26 mai 2022 Claude Perreault et Pierre Thibault, fondateurs d’Epitopea, une compagnie porteuse d’espoir pour le traitement du cancer
Fondée en 2021, la société de biotechnologie transatlantique Epitopea voit le jour à la suite de collaborations entre les équipes de Claude Perreault et de Pierre Thibault, tous deux chercheurs principaux à l’IRIC. L’organisation a pour mission de développer des immunothérapies pour traiter les différents types de cancers en ciblant une nouvelle classe d’antigènes.
![]()
-
20 mai 2022 Un soutien de 3 millions de dollars du Réseau de cellules souches pour étudier de nouvelles façons d’utiliser les cellules souches sanguines dans le traitement des leucémies
Guy Sauvageau, chercheur principal à l’IRIC, hématologue et professeur titulaire au Département de médecine de la Faculté de médecine de l’Université de Montréal, est récipiendaire d’un financement majeur d’une valeur de 3 millions de dollars sur trois ans. Le projet mené par Dr Sauvageau est composé de 8 groupes de recherche dont ceux de Philippe Roux et d’Étienne Gagnon, tous deux chercheurs à l’IRIC.
![]()
-
16 mai 2022 Vincent Archambault nommé professeur titulaire au Département de biochimie et médecine moléculaire de l’Université de Montréal
L’IRIC est fier d’annoncer la promotion de Vincent Archambault, chercheur principal et directeur de l’unité de recherche sur la régulation du cycle cellulaire, comme professeur titulaire au Département de biochimie et médecine moléculaire de l’Université de Montréal.
![]()
-
12 mai 2022 Les Rendez-vous Audace 2022 : la Dre Eralda Kina répond à vos questions
Les Rendez-vous Audace de l’IRIC, tenus le 27 avril dernier, ont rassemblé André Robitaille et trois interlocutrices inspirantes autour du thème « Un monde en transformation, une relève en action ». Eralda Kina, oncologue et doctorante à l’IRIC dans le laboratoire de Claude Perreault, a quant à elle discuté de son expérience de clinicienne et des grands espoirs qu’elle fonde en la recherche en immunologie et en cancérologie. Dre Kina a généreusement accepté de répondre aux questions du public reçues lors de la diffusion des Rendez-vous Audace.
![]()
-
9 mai 2022 Geneviève Deblois est honorée par les Instituts de recherche en santé du Canada
Geneviève Deblois, chercheuse principale à l’IRIC et professeure adjointe à la Faculté de pharmacie de l’Université de Montréal, est lauréate du Prix de début de carrière en recherche sur le cancer 2022. Ce prix, remis par l’Institut du cancer des Instituts de recherche en santé du Canada (IRSC), reconnaît l’excellence de la recherche réalisée au Canada. Il est remis aux nouveaux chercheurs et chercheuses ayant présenté les demandes de subventions les mieux classées du concours d’automne des IRSC, volet Projet.
![]()
-
28 avril 2022 Identification d’un nouveau rôle clé pour les microtubules interphasiques en entrée de mitose
Au début de la division cellulaire, les cellules s’arrondissent entre autres via la réorganisation de leur cortex. Parmi les protéines impliquées dans cette morphogenèse, on trouve la famille des protéines ERM (ezrine, radixine et moésine). L’équipe du professeur Sébastien Carréno, directeur de l’unité de recherche sur les mécanismes de la morphogénèse cellulaire au cours de la mitose et de la migration, a voulu identifier le signal d’activation de ces protéines en entrée de mitose. Leurs travaux ont mis en lumière un nouveau mécanisme impliquant les microtubules interphasiques dans la régulation de l’arrondissement cellulaire en entrée de mitose. Le projet, mené par l’étudiant au doctorat Kévin Leguay, fait l’objet d’une publication dans le Journal of Cell Biology.
![]()
-
20 avril 2022 Nouvelle entente de collaboration internationale de recherche en découverte de médicaments
L’IRIC se réjouit de la signature d’un accord de collaboration entre Ono Pharmaceutical Co., Ltd., une des plus grandes sociétés pharmaceutiques de stade clinique du Japon, Domain Therapeutics S.A. et l’Université de Montréal, qui vise à découvrir de nouvelles petites molécules ciblant les récepteurs couplés aux protéines G (RCPG) dans le traitement de maladies métaboliques.
![]()
-
12 avril 2022 Publication de deux études caractérisant la sélectivité de couplage des récepteurs couplés aux protéines G
Les deux tiers des hormones humaines ainsi que le tiers des médicaments ciblent et activent la famille des récepteurs couplés aux protéines G (RCPG). Pour un même récepteur, différents ligands peuvent engager sélectivement différents sous-ensembles de voies de signalisation. La cartographie des effecteurs pouvant être engagés par un récepteur donné est essentielle pour comprendre les processus physiologiques de même que pour concevoir des médicaments plus sûrs. L’équipe du professeur Michel Bouvier, directeur de l’unité de recherche en pharmacologie moléculaire et directeur général de l’IRIC, s’est penchée sur la caractérisation de la sélectivité de couplage des RCPG.
![]()
-
7 mars 2022 L’IRIC célèbre la Journée internationale des femmes
L’IRIC profite de la Journée internationale des droits des femmes pour reconnaître et souligner la contribution exceptionnelle de toutes ses scientifiques qui travaillent à faire la différence.
![]()
-
23 février 2022 Doctorante à l’IRIC, Assya Trofimov est lauréate de la prestigieuse bourse postdoctorale Mahan
Assya Trofimov, étudiante au doctorat en co-direction dans les laboratoires de Claude Perreault et de Sébastien Lemieux, a obtenu la prestigieuse bourse postdoctorale Mahan. Le concours, tenu annuellement par le Fred Hutchison Cancer Research Center (Fred Hutch) de Seattle, récompense les candidatures exceptionnelles en offrant un support financier de 21 mois pour réaliser un projet de recherche dans un de ses laboratoires de biologie computationnelle.
![]()
-
17 février 2022 Trois événements sportifs au profit de l’IRIC
En 2022, la communauté de l’IRIC aura l’occasion de participer à trois événements sportifs de renom : Les Défis du Parc national de la Mauricie, Les Grands Prix Cyclistes de Québec et de Montréal, ainsi que le Marathon Beneva de Montréal.
![]()
-
11 février 2022 L’IRIC souligne la Journée internationale 2022 des femmes et des filles de science
À l’occasion de cette journée symbolique, l’IRIC est fier de souligner la contribution exceptionnelle de toutes ses membres dans la recherche contre le cancer.
![]()
-
4 février 2022 Quatre laboratoires de l’IRIC reçoivent une subvention des Instituts de recherche en santé du Canada
Lors du concours d’automne 2021, quatre équipes de recherche de l’IRIC se sont vues octroyer des prestigieuses subventions.
![]()
-
4 février 2022 La leçon d’une vie du marathonien Jean Mireault
En cette Journée mondiale contre le cancer, l’IRIC désire souligner la généreuse contribution de monsieur Jean Mireault envers notre cause. Le 11 octobre 2021, monsieur Mireault a participé au marathon de Boston en l’honneur de sa mère décédée très jeune des suites du cancer. Bien que sa course ne se soit pas déroulée comme il l’espérait en raison d’un malaise inattendu à la mi-parcours, monsieur Mireault en retire une leçon des plus inspirantes pour chacun de nous. Dans un témoignage empreint de franchise, il nous raconte dans quel état d’esprit il a pu compléter, non pas sans heurt, la deuxième partie de son marathon.
![]()
-
28 janvier 2022 Renouvellement du mandat de Michel Bouvier au poste de directeur général de l’IRIC
À l’issue d’une séance du comité exécutif, tenu le 7 décembre 2021, l’Université de Montréal a annoncé la poursuite du mandat de Michel Bouvier au poste de directeur général de l’IRIC pour un troisième mandat d’un an.
![]()
-
27 janvier 2022 L’IRIC obtient un financement majeur pour élaborer une chimiothèque intelligente
Dans le cadre de la première phase de Médicament Québec, l’IRIC a récemment obtenu un financement majeur de 3 200 045 $ pour le projet Accroissement des capacités et de la qualité de chimiothèques pour la découverte de médicaments.
![]()
-
26 janvier 2022 Katherine Borden est honorée par la Société canadienne des biosciences moléculaires
La Société canadienne pour les biosciences moléculaires (SCBM) remet le prestigieux Prix du Scientifique chevronné de Canadian Science Publishing 2022 à Katherine Borden, chercheuse principale à l’IRIC et professeure titulaire au Département de pathologie et biologie cellulaire de la Faculté de médecine de l’Université de Montréal.
![]()
-
20 janvier 2022 Un important soutien des National Institutes of Health pour étudier de nouvelles façons de cibler la leucémie myéloïde aiguë
La professeure Katherine Borden, chercheuse principale qui dirige l’unité de recherche en structure et fonction du noyau cellulaire de l’IRIC, a reçu une subvention d’une valeur de 1,47 million de dollars américains (1,85 million de dollars canadiens) sur cinq ans. Le financement octroyé par les National Institutes of Health (NIH), principal organisme subventionnaire de la recherche biomédicale aux États-Unis, soutiendra son projet de recherche visant à élucider les mécanismes moléculaires de transformation tumorale médiée par la protéine eIF4E.
![]()
-
18 janvier 2022 Identification d’une nouvelle voie de signalisation oncogénique dans le développement du carcinome hépatocellulaire
Le carcinome hépatocellulaire (CHC) est le 6e cancer le plus fréquemment diagnostiqué, et arrive au troisième rang des cancers les plus meurtriers dans le monde. Malgré ces chiffres imposants, les quelques traitements disponibles actuellement n’ont que des effets modestes chez les personnes atteintes, qui sont souvent diagnostiquées à un stade tardif de la maladie. Une plus grande compréhension mécanistique du développement du CHC est requise pour le contrer plus efficacement par de nouvelles thérapies ciblées. L’équipe du professeur Sylvain Meloche, directeur de l’unité de recherche en signalisation et croissance cellulaire de l’IRIC, a récemment mis en lumière une voie de signalisation oncogénique précédemment inconnue pour le CHC. Jean-Philippe Guégan et Marjorie Lapouge sont les co-premiers auteurs de l’article publié en janvier dans le journal Science Signaling.
![]()
-
14 décembre 2021 Bourses de maîtrise et de doctorat de l’IRIC – Récipiendaires du Concours Automne 2021
À l’issue du Concours de bourses de maîtrise et de doctorat de l’IRIC tenu cet automne, l’Institut est fier d’annoncer les 14 récipiendaires de cette édition.
L’objectif du concours est d’appuyer les étudiantes et les étudiants de l’Institut qui ont un excellent dossier académique et de recherche, mais qui ne bénéficient pas de bourse nominale majeure.
Félicitations à toutes et à tous!
![]()
-
13 décembre 2021 L’IRIC, un acteur clé du projet Acuité-Québec: 27M$ pour accélérer la découverte de nouveaux médicaments
L’Institut de recherche en immunologie et en cancérologie (IRIC) de l’Université de Montréal se réjouit de faire partie du projet Acuité-Québec, une initiative visant à favoriser la découverte de nouveaux médicaments.
![]()
-
16 novembre 2021 Recrutement à la direction scientifique de l’IRIC
L’IRIC sollicite des candidatures pour le poste de directeur/directrice scientifique et de chercheur principal/chercheuse principale à l’institut. On recherche une ou un scientifique chevronné ayant une carrière exceptionnelle afin de superviser le développement scientifique de l’Institut tout en menant son propre programme en recherche fondamentale et/ou translationnelle dans des domaines liés au cancer.
![]()
-
15 novembre 2021 Organisez une collecte de fonds pour soutenir les efforts de recherche en cancérologie
En cette Journée de la philanthropie, l’IRIC met en ligne un nouvel outil pour tous ceux et celles désirant organiser une activité de collecte de fonds au profit de l’Institut.
![]()
-
30 septembre 2021 Trang Hoang remporte le prix Mentor scientifique 2021 du Club de Recherches Cliniques du Québec
Trang Hoang, chercheuse principale à l’Institut de Recherche en Immunologie et en Cancérologie (IRIC) et professeure titulaire au Département de pharmacologie de la Faculté de médecine de l’Université de Montréal, s’est vu décerner le prix Mentor scientifique 2021 du Club de Recherches Cliniques du Québec (CRCQ).
![]()
-
21 septembre 2021 Un forum pour la semaine de l’égalité des sexes au Canada
En tant qu’institution, l’IRIC cherche à promouvoir l’équité et à accroître la diversité et l’inclusion, sous toutes ses formes, dans ses différents programmes.
![]()
-
29 juillet 2021 L’équipe de Pierre Thibault partage ses connaissances sur les stratégies protéomiques basées sur la spectrométrie de masse utilisées pour étudier les modifications de type UBL
Le groupe de Pierre Thibault, chercheur principal à l’IRIC et professeur au Département de chimie de l’UdeM, avec un collègue du Centre médical universitaire de Leiden aux Pays-Bas, a récemment publié un article de synthèse exhaustif dans la revue Nature Reviews Methods Primers pour informer les chercheurs de tous niveaux sur la variété des stratégies protéomiques basées sur la spectrométrie de masse utilisées pour étudier les modifications de type ubiquitine (UBL) et décrire le genre de données pouvant être générées par ces approches.
![]()
-
21 juin 2021 Brian Wilhelm est récipiendaire d’un financement majeur dans le cadre du nouveau Programme d’intégration de la génomique initié par Génome Québec
Brian Wilhelm, chercheur principal à l’IRIC et professeur agrégé au Département de médecine de la Faculté de médecine de l’Université de Montréal, est récipiendaire d’un financement majeur dans le cadre du nouveau Programme d’intégration de la génomique – volet santé humaine, initié par Génome Québec en collaboration avec l’Oncopole.
![]()
-
17 juin 2021 L’IRIC félicite l’engagement du gouvernement du Québec : 13 M$ investis pour fédérer les acteurs en découverte et production de médicaments
L’IRIC se réjouit de la création de « Médicament Québec », un pôle stratégique d’importance ayant pour mission de favoriser une meilleure autonomie et d’accroître le dynamisme du Québec en matière de découverte, de développement ainsi que de production de médicaments.
![]()
-
3 juin 2021 Nomination de Clarissa Desjardins et renouvellement des mandats de Jacques Bernier et de Robert Paré au sein du CA de l’IRIC
L’IRIC est heureux d’annoncer la nomination de Clarissa Desjardins à titre de nouveau membre du conseil d’administration ainsi que le renouvellement des mandats de M. Jacques Bernier et de M. Robert Paré comme membres du CA par le comité exécutif de l’Université de Montréal.
![]()
-
26 mai 2021 L’IRIC participe au prochain Forum de la Chambre de commerce du Montréal métropolitain
Lundi, le 31 mai prochain, l’IRIC participera au Forum stratégique Universités, cégeps, entreprises : collaborer pour une économie forte, innovante et socialement responsable, une initiative de la Chambre de commerce du Montréal métropolitain et du FRQS.
![]()
-
17 mai 2021 Trang Hoang est la lauréate du prix Jeanne Manery Fisher 2021 de la SCBM
Trang Hoang, chercheuse principale à l’Institut de recherche en immunologie et en cancérologie (IRIC) et professeure titulaire au Département de pharmacologie de la Faculté de médecine de l’Université de Montréal, est la lauréate du prix Jeanne Manery Fisher 2021 de la Société canadienne pour les biosciences moléculaires (SCBM).
![]()
-
14 mai 2021 Les Rendez-vous Audace 2021 : 320 000 dollars amassés pour soutenir les efforts de recherche de l’IRIC en cancérologie
Exceptionnellement cette année, l’Institut de recherche en immunologie et en cancérologie (IRIC) de l’Université de Montréal a présenté une formule virtuelle de son traditionnel événement-bénéfice Audace : Les Rendez-vous Audace. Pour l’occasion, environ 615 personnes en provenance de 8 pays ont assisté aux trois conférences présentées gratuitement, et près d’une vingtaine de commanditaires ont soutenu l’événement. Grâce à la générosité de nos partenaires et donateurs, un montant de 320 000 $ a été amassé pour accélérer la découverte de meilleures thérapies au bénéfice des patients.
![]()
-
11 mai 2021 Conférence de Roger D. Kornberg – Prix Nobel de chimie
Le 20 mai prochain, l’IRIC et l’Université de Montréal auront l’honneur d’accueillir Roger D. Kornberg, Prix Nobel de chimie en 2006, dans le cadre d’une conférence intitulée : « Chromosome Structure and Transcription ».
![]()
-
26 avril 2021 Des criblages à l’échelle du génome identifient un nouveau gène qui atténue la réponse aux dommages à l’ADN dans les cellules humaines avec des télomères érodés
Les télomères sont des séquences d’ADN qui servent de capuchons structuraux pour protéger les extrémités des chromosomes contre la dégradation, l’effilochage et la fusion avec d’autres chromosomes. Ils jouent un rôle important dans le maintien de l’intégrité du génome, mais dans la plupart des cellules de notre corps, les télomères deviennent plus courts à chaque division cellulaire puisque l’activité de l’enzyme de maintenance des télomères (TERT) est progressivement réprimée. Après un raccourcissement suffisant des télomères, leur fonction protectrice est perdue, activant le gène suppresseur de tumeur p53 et la réponse aux dommages à l’ADN. Cela conduit à un état non prolifératif appelé sénescence dans les cellules normales, ou à la mort cellulaire dans les cellules cancéreuses. On pense que ces effets inhibiteurs sur la prolifération cellulaire sont un mécanisme important pour empêcher la prolifération de cellules endommagées et la formation de tumeurs.
![]()
-
26 avril 2021 Une levure pathogène a plusieurs tours dans son sac
Les infections par la levure Candida albicans constituent un problème de santé publique important et une complication commune chez les individus immunodéprimés comme les sidéens, les patients en chimiothérapie et les patients ayant subi une transplantation d’organe. Bien qu’il existe certains traitements, leur efficacité peut être compromise par l’apparition de souches résistantes et l’identification de nouveaux antifongiques est hautement désirable. Or, il y a quelques années, une équipe de l’IRIC a identifié la nicotinamide (NAM), une forme de la vitamine B3, comme un traitement antifongique potentiel.
![]()
-
21 avril 2021 Conférence de Guy Sauvageau à la CCMM: entre innovation, recherche et philanthropie
En conférence à la Chambre de commerce du Montréal métropolitain, Guy Sauvageau a annoncé la création d’une chaire de recherche en chémogénomique des cellules souches sanguines.
![]()
-
13 avril 2021 La coordination spatiotemporelle: un aspect clé permettant aux cellules de se diviser correctement
Les enzymes régulatrices de la division cellulaire doivent être soumises à un contrôle spatiotemporel leur permettant d’accéder aux structures cellulaires qu’elles contrôlent seulement au moment opportun. La ségrégation des chromosomes durant la mitose est l’événement le plus crucial de la division cellulaire. La coordination spatiotemporelle est donc fondamentale au bon déroulement de la mitose.
![]()
-
1er avril 2021 TMEM16F: une protéine avec un rôle clé dans la régulation de l’activité des lymphocytes T
Par Fatéma Dodat
Comprendre la régulation de l’activité des cellules T représente un enjeu crucial pour le développement d’une immunité contre les infections, mais aussi dans le cancer. Une étude menée par l’équipe du chercheur Etienne Gagnon révèle que TMEM16F, une molécule favorisant l’échange des constituants entre les feuillets de la bicouche lipidique d’une membrane cellulaire, est impliquée dans cette activation.
![]()
-
30 mars 2021 Un pas de plus est franchi vers un vaccin anticancer
Claude Perreault et son équipe publient cette semaine un article important sur la mise au point d’un vaccin thérapeutique contre un cancer du sang.
![]()
-
26 février 2021 L’IRIC entrevoit un traitement pour l’obésité sévère
Par Mathieu-Robert Sauvé, UdeM Nouvelles
Michel Bouvier présente son étude sur une piste de traitement pour une forme d’obésité d’origine génétique.
![]()
-
17 février 2021 Michel Bouvier, DG de l’IRIC, participe au symposium pancanadien sur l’avenir de la découverte et la production de médicaments au Canada
L’Institut de recherche en immunologie et cancérologie (IRIC) de l’Université de Montréal est fier d’annoncer la participation de Michel Bouvier, Directeur général de l’Institut, récemment récipiendaire du prix Killam en sciences de la santé, à l’événement virtuel « Building Biotech : Science and Talent Accelerating Biomedical Innovation, a Pan-Canadian Showcase and Dialogue ». Ce symposium a lieu aujourd’hui, le 17 février 2021 et est organisé par PRiME à l’Université de Toronto.
![]()
-
4 février 2021 Journée mondiale contre le cancer 2021 : Aidez-nous à vaincre le cancer!
La Journée mondiale contre le cancer est célébrée annuellement, le 4 février, aux quatre coins du globe. Elle permet de souligner les incroyables avancées de la recherche contre le cancer qui permettent de sauver de plus en plus de vies et génèrent un espoir indéniable. En souvenir de ceux qu’on aime qui sont partis trop tôt ou en hommage à ceux qui luttent actuellement contre la maladie, soulignons ensemble cette Journée, le progrès que nous avons fait et celui qu’il nous reste à parcourir.
![]()
-
3 février 2021 Michel Bouvier est récipiendaire du prix Killam 2021 en sciences de la santé
Michel Bouvier, Directeur général de l’IRIC et Professeur au Département de biochimie et médecine moléculaire de la Faculté de médecine de l’Université de Montréal, est récipiendaire du prix Killam 2021 en sciences de la santé.
![]()
-
26 janvier 2021 Bourses de maîtrise et de doctorat de l’IRIC – Récipiendaires du Concours Automne 2020
À l’issue du Concours de bourses de maîtrise et de doctorat de l’IRIC tenu cet automne, l’Institut est fier d’annoncer les 17 récipiendaires de cette édition.
![]()
-
12 janvier 2021 La molécule UM171 continue de donner des résultats encourageants
L’équipe de Guy Sauvageau a publié un article démontrant le mécanisme d’action de la molécule UM171.
![]()
-
2 décembre 2020 Nanotechnologies : l’équipe du laboratoire Bouilly relève des principes importants dans la conception des biocapteurs
Au cours de la dernière décennie, les progrès dans le domaine des nanotechnologies, en particulier la découverte de nouveaux nanomatériaux, ont catalysé des innovations remarquables dans la création de différents biocapteurs, c’est à dire des dispositifs d’analyse permettant de détecter et d’étudier les propriétés de nombreuses molécules biologiques. Il existe de nombreux types de biocapteurs et il est souvent difficile de comparer leurs performances et d’identifier les approches les plus prometteuses.
![]()
-
9 novembre 2020 Le projet de Sébastien Lemieux et de son équipe est récipiendaire du concours DOCC
Génome Québec, IVADO et l’Oncopole se sont réuni pour organiser le concours « Données omiques contre le cancer » (DOCC). Cette initiative vise à soutenir des projets développant des applications et des outils d’intelligence artificielle utilisés pour mieux exploiter les ensembles de données générées par la génomique et l’étude du cancer.
Le projet de Sébastien Lemieux, chercheur principal à l’IRIC et de son équipe fait partie des 5 projets récipiendaires du programme.
![]()
-
20 octobre 2020 L’équipe des affaires académiques de l’IRIC reçoit le prix d’excellence en enseignement
L’IRIC est fier d’annoncer l’obtention du prix d’excellence en enseignement Catégorie Innovation – Soutien à la réussite étudiante par son équipe des affaires académiques : Sébastien Carréno, Julie Mantovani, Evelyne Muhire, Pascale Le Thérizien. Cette reconnaissance attribuée par le Vice-rectorat aux affaires étudiantes et aux études de l’Université de Montréal souligne la contribution exceptionnelle de l’équipe au soutien à la réussite étudiante.
![]()
-
15 octobre 2020 Tournée de recrutement étudiant 2020 : une édition virtuelle cet automne
L’équipe des affaires académiques de l’IRIC lance chaque automne une tournée de recrutement étudiant « IRIC sur la route ». Cette année, dans le contexte exceptionnel engendré par la pandémie de COVID-19, nos représentantes partent à la rencontre des étudiant.e.s virtuellement. Elles participeront à plusieurs salons d’études supérieures organisés sur la toile par diverses universités canadiennes.
![]()
-
14 octobre 2020 Un soutien au bénéfice de l’IRIC et du Département de biochimie et médecine moléculaire de l’UdeM
Dans le cadre d’une vaste campagne de dons planifiés menée par le Réseau des diplômés et des donateurs de l’Université de Montréal, Michel Bouvier, directeur général de l’IRIC et sa conjointe, Muriel Aubry, se sont engagés à faire un leg testamentaire au profit de l’Institut et du Département de biochimie et médecine moléculaire de l’UdeM pour soutenir la recherche contre le cancer et la formation de la relève scientifique.
![]()
-
13 octobre 2020 Rompre le paradigme de la coiffe de l’ARN
Cette découverte d’une équipe de chercheurs de l’IRIC pourrait bientôt être enseignée dans les cours de biologie moléculaire. Le laboratoire de Katherine Borden a récemment publié une étude dans la revue PNAS qui démontre que l’activité des ARN peut être régulée d’une nouvelle manière: en modulant une modification de l’ARN appelée « capping ».
![]()
-
4 septembre 2020 Trois chercheurs de l’IRIC reçoivent un appui substantiel de la Fondation canadienne pour l’innovation
Le 18 août 2020, la Fondation canadienne pour l’innovation (FCI) a annoncé les projets de recherche sélectionnés qui bénéficieront de son soutien financier. Cet appui substantiel permet notamment aux chercheuses et chercheurs de s’outiller en équipements hautement spécialisés et locaux avant-gardistes, et de recruter et maintenir en poste des scientifiques réputés.
![]()
-
6 août 2020 Des cribles pangénomiques revèlent que le resvératrol induit un stress réplicatif sur les cellules humaines
Le resvératrol (RSV) est un composé naturel présent dans de nombreuses plantes, y compris la peau des raisins (et du vin), les myrtilles, les framboises, les mûres et les arachides. Il a beaucoup attiré l’attention des chercheurs en raison de ses propriétés bénéfiques rapportées dans des modèles expérimentaux tels que les levures, les vers nématodes, les mouches des fruits et les souris, y compris l’allongement de la durée de vie dans certaines conditions. Un rôle causal du RSV dans la santé humaine n’a pas encore été établi.
![]()
-
26 février 2026 L’IRIC souligne la Journée internationale des femmes et filles de science!
Le 21 février dernier, l’IRIC était présent au Centre des sciences de Montréal pour la journée des Femmes et filles de science. Cet événement permet de rencontrer des femmes passionnées qui œuvrent dans une multitude de domaines, des technologies à l’environnement, de la santé à l’aérospatiale.
-
26 juin 2025 UM171 franchit de nouvelles frontières
Il y a de cela quelques années à peine, l’espoir était quasi vain pour les personnes atteintes d’hémopathies malignes nécessitant une greffe de cellules souches, notamment les leucémies aiguës et les syndromes myélodysplasiques. Aujourd’hui, grâce aux travaux de Guy Sauvageau et Anne Marinier, de nouvelles options de traitement font graduellement leur entrée sur le marché, à l’échelle mondiale. Respectivement experts en génétique moléculaire des cellules souches et en chimie médicinale, les deux scientifiques de l’IRIC et professeur(e)s à l’UdeM sont à l’origine de la découverte de la molécule UM171, laquelle a vu le jour en 2014.
-
29 septembre 2022 Des jeunes mettent sur pied une collecte de fonds pour l’IRIC
L’IRIC souligne l’acte de générosité du Collège Nouvelles Frontières. Lors d’une de leurs « journées civiles payantes » où les élèves obtiennent le droit de troquer leur uniforme pour les vêtements de leur choix, ces derniers profitent également de cette journée attendue pour amasser des fonds pour soutenir la communauté.
-
13 mai 2022 SQSV 2022-2025 : Des nouvelles encourageantes pour l’industrie!
L’IRIC se réjouit de l’annonce du ministre de l’Économie et de l’Innovation du Québec, monsieur Pierre Fitzgibbon, quant au dévoilement de la Stratégie québécoise des sciences de la vie 2022-2025 dans le cadre de l’événement phare Effervescence. Sous le thème « Utiliser notre ingéniosité pour faire évoluer la santé », la stratégie, mise à jour dans le contexte de la COVID-19, propose des actions concrètes et innovantes pour valoriser cette industrie clé de l’économie du Québec et en favoriser l’essor.
-
12 avril 2022 Journée mondiale de la santé : Contribuons à notre avenir collectif
Le 7 avril dernier avait lieu la Journée mondiale de la santé, qui vise cette année à souligner l’importance de préserver la santé des êtres humains et de la planète; une occasion pour l’IRIC de réitérer l’apport inestimable de ses donateurs et donatrices.
-
24 janvier 2022 Investir dans la recherche : un geste qui rapporte
Un éventuel vaccin thérapeutique contre le cancer des ovaires, un nouveau traitement contre la leucémie et une molécule qui pourrait même court-circuiter jusqu’à 70 % de tous les types de cancers… Ces trois projets en cours de développement à l’IRIC ont bénéficié de fonds provenant de donations privées. Parmi ceux-ci, les titres cotés en bourse constituent une façon avantageuse de contribuer à la prochaine génération de traitements contre le cancer.
-
17 janvier 2022 Ciné-conférence: Le cancer pédiatrique : un accompagnement scientifique et humain
L’IRIC en collaboration avec la Faculté de médecine et le réseau des diplômés et des donateurs de l’UdeM offriront une édition spéciale des Ciné-conférences le 3 février 2021, dans le cadre de la Journée mondiale contre le cancer.
-
7 octobre 2021 L’IRIC accueille deux nouveaux agents de communication
Nous sommes heureux de vous annoncer l’entrée en poste de Thomas Milan (27 septembre) et de Myreille Larouche (14 octobre) au poste d’agents de communication et relations médias. L’IRIC a à cœur d’encourager sa relève. Nous sommes ainsi fiers et enthousiastes à l’idée d’avoir deux scientifiques, dotés de grandes aptitudes communicationnelles, comme nouveaux ambassadeurs de l’Institut.
-
4 octobre 2021 -
22 septembre 2021 Tournée de recrutement étudiant 2021 : une édition de nouveau virtuelle cet automne
L’équipe des affaires académiques de l’IRIC lance chaque automne une tournée de recrutement étudiant « IRIC sur la route ». Cette année, nos représentantes partent à la rencontre des étudiant.e.s virtuellement. Elles participeront à plusieurs salons d’études supérieures organisés sur la toile par diverses universités canadiennes.